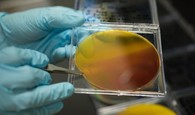

23-ene-2018
La conformación de los Comités Regionales de Cambio Climático, fue propuesta en el “Plan Nacional de Adaptación al Cambio Climático (PNACC)”, en 2014 y nace de la necesidad de fortalecer acciones de cambio climático en los territorios, en concordancia con la política climática nacional y el desarrollo de las regiones.

23-ene-2018
Fuentes del Instituto Tecnológico de la Industria Agroalimentaria (Ainia) han informado de un programa impulsado por instituciones tecnológicas y empresas agrícolas que desarrolló un sistema eco-eficiente de reutilización de hasta mil litros de agua por hora, procedente del lavado de cítricos, denominado Eco3Wash.

20-ene-2018
Ciren entrega detalle de 17 especies priorizadas, en base a los cambios que enfrentarán según cambio climático, los cuales que puede ser todo un desafío y/o una oportunidad regional.

19-ene-2018
El ingeniero agrónomo Franco Novoa, el biólogo Julio Becerra y el médico veterinario Rolando Calvanese, están desarrollando una innovadora vacuna orgánica que apunta a hacer más resistentes a las plantas de arándanos y de cerezos a dos enfermedades que generan un grave daño económico para los huertos.

19-ene-2018
La incubadora alberga 400 abejas reinas, para después incorporar cada una a otra colmena y así evitar su extinción.

12-ene-2018
2018 es un buen momento para dar pasos sostenibles en el sector del envasado. Las excusas como "demasiado caro" y "suministro escaso" ya no son válidas. "Somos los primeros en Europa en fabricar con éxito platos y bandejas totalmente compostables para frutas y hortalizas en el mercado", dice Maarten Kimman, de Biopack packaging en Appingedam. "En lo que respecta al precio, estamos al nivel del plástico y tenemos suficiente capacidad de producción. Se avecina un gran avance. Ampliaremos nuestra capacidad rápidamente el próximo año".

10-ene-2018
Bajo el nombre “Revisión de Políticas de Transformación Productiva de Chile”, la Organización para la Cooperación y el Desarrollo Económicos (Ocde) lleva a cabo un informe en el que revisa la agenda de desarrollo productivo de Chile y expone cómo los actuales cambios globales y tecnológicos ofrecen al país nuevas oportunidades para su transformación económica.

09-ene-2018
Antialérgico, mejora el sistema inmunológico y ayuda al hígado, entre otros beneficios, explica académico. Son de diversos colores y formas. Las hay de tonalidades fuertes, apagadas, de hojas más redondas o alargadas.

08-ene-2018
Un equipo de investigadores de la universidad del Estado de Iowa (Estados Unidos) ha desarrollado un sistema de sensores para plantas fabricados con grafeno que proporcionan información sobre la cantidad de agua en los cultivos a los agricultores.

06-ene-2018
Los servicios básicos, el drenaje de aguas y la eficiencia energética son cada vez más sensibles a los gases efecto invernadero. El gobierno elaboró un plan especial para las urbes que sería aprobado en enero por el Comité de Minsitros.

05-ene-2018
Documento fija los lineamientos para el período 2017-2030 en materia de protección de biodiversidad, con el objeto de resguardar el patrimonio natural del país, ponerlo en valor, revertir o reducir las consecuencias de la pérdida o degradación de ecosistemas, y promover su uso sustentable en el desarrollo.

05-ene-2018
Libro de la FAO analiza el estado de la polinización y los servicios que brindan múltiples especies animales al desarrollo de la agricultura en Chile, Paraguay y Perú.

04-ene-2018
La hidromiel es una bebida alcohólica con una concentración que varía del 10% al 15% y que se obtiene a partir de la fermentación de una mezcla de agua y miel.

04-ene-2018
El objetivo de la iniciativa, fue conocer en detalle el contenido nutricional, la eficiencia y la forma de disponibilidad del nitrógeno, fósforo y potasio, de los principales fertilizantes orgánicos autorizados.

03-ene-2018
s problemas de disponibilidad de mano de obra que presenta el sector agrícola.

03-ene-2018
Más de 3.534 millones de pesos serán distribuidos este año entre 234 proyectos aprobados en la convocatoria del Concurso Silvoagropecuario 2018, herramienta creada hace dos décadas para fomentar las exportaciones de alimentos frescos o procesados y de productos forestales no industriales del país.

02-ene-2018
La Araucanía cuenta con muchos recursos naturales que deben ser aprovechados, y cultivados, para generar recursos a miles de familias.

02-ene-2018
Con el objetivo de apoyar la profesionalización y modernización del rubro apícola en el Maule, el Centro de Formación Técnica (CFT) San Agustín y la Mesa Apícola Regional firmaron un acuerdo amplio de colaboración.

29-dic-2017
Esta plataforma pone a disposición del público más de 200 conjuntos de datos, visualizaciones y acceso a toda la normativa y estudios del sector energético en Chile.

29-dic-2017
Tras casi tres años de trabajo, los distintos ensayos para encontrar el mejor mecanismo de domesticación y cosecha del maqui comienzan a arrojar interesantes resultados (Mundo Agropecuario).

28-dic-2017
El evento, contó con la presencia de representantes del sector productivo y de la investigación como Frutexsa, Natural Chile, Mi Fruta S.A., Gallardo Export y CONICYT, entre otros.

28-dic-2017
Seis iniciativas presentadas por la Universidad de Talca fueron beneficiadas por el Gobierno Regional del Maule para recibir asignación de recursos del Fondo de Innovación y Competitividad (FIC) 2017. Este instrumento de financiamiento aprobó 739.143.606 millones de pesos para ejecutar proyectos que fortalecerán el desarrollo tecnológico y el sistema de innovación regional.

28-dic-2017
En el Fogón del Fundo El Silencio Km 25, el pasado miércoles 20 de diciembre se realizó esta actividad de cierre de una interesante iniciativa en torno a los Productos Forestales No Madereros de la región de Aysén.

22-dic-2017
Si bien los desechos y riles de las producciones ganaderas y frutícolas por años fueron vistos como un problema que implica costos, hoy se transforman en materia prima que genera ahorros en energía, fertilizantes y disminuyen la huella de carbono de las producciones.

22-dic-2017
Seis pilotos de un nuevo modelo para la enseñanza técnico profesional se implementarán el 2018 gracias a este centro especializado de la UCSC.

22-feb-2018
Datos satelitales dieron a conocer nuevas estimaciones que muestran que las proyecciones más pesimistas de los modelos climáticos no estaban lejos de la realidad. El estudio da cuenta de una aceleración en el proceso de aumento de mar, lo cual sería explicado por el creciente y rápido derretimiento de hielos en Groenlandia y la Antártica.

22-mar-2019
Un equipo de investigadores y extensionistas del INTA avanza en el desarrollo de un sensor electrónico que permitirá registrar los puntos en los que se dañan las cerezas durante el proceso de empaque. Beneficiará la calidad final de la fruta que se comercializa a diferentes mercados.

20-mar-2019
royecto Drasbio propone sustituir los artículos plásticos desechables por productos ecológicos biodegradables elaborados con residuos agrícolas en desuso para contribuir a la reducción del impacto al medio ambiente. La idea es de la estudiante de Licenciatura en Diseño Industrial, Fernanda Ramírez, quien junto a un equipo de egresados de la U. de Santiago, comenzó a desarrollarla en 2017 (Mundo Agropecuario-USACh).

13-mar-2019
La agencia de extensión del Centro Nacional de Tecnología Agropecuaria y Forestal “Enrique Álvarez Córdova” (CENTA) en Usulután realizó una gira de campo para observar el cultivo de pipián protegido con malla flotante.

12-mar-2019
La Red de Gestión de la Innovación (Red INNOVAGRO) lanzó su convocatoria para participar por el Premio INNOVAGRO 2019 en su sexta edición en las categorías de Innovación Tecnológica, Innovación Institucional e Innovación Social, que será entregado en junio próximo.

05-mar-2019
Una delegación integrada por los entomólogos Natalia Olivares Pacheco y Fernando Rodríguez Alvarez, se trasladó hasta la isla para realizar actividades comprometidas en el proyecto “Manejo Integrado de Plagas Biointensivo con productores familiares hortofrutícolas de Rapa Nui”, que cuenta con el apoyo de la Fundación para la Innovación Agraria (FIA) y el Instituto de Desarrollo Agropecuario (INDAP) y cuyo propósito es reducir las aplicaciones de agroquímicos a las hortalizas y frutales en Rapa Nui.

04-mar-2019
Fruit Logística publica cada año un vistazo a la actividad económica de las frutas y hortalizas en el documento European Statistics Handbook. La industria hortícola moderna utiliza capital, tecnología y conocimiento.

04-mar-2019
Un total de 44 técnicos, entre extensionistas y 5 investigadores, del Centro Nacional de Tecnología Agropecuaria y Forestal “Enrique Álvarez Córdova” (CENTA) ampliaron sus conocimientos en lo relacionado con el manejo del agua en el suelo que se llevó a cabo los días 25, 26 y 27 de febrero.

01-mar-2019
Iniciativa liderada por la Universidad Católica de Temuco – y apoyada por la Fundación para la Innovación Agraria (FIA)– trabaja en un proceso productivo piloto para el copihue, para desarrollar artesanía en fibra de nuestra flor nacional.

29-mar-2018
Ministro de esa cartera, Antonio Walker, se reunió en la zona con gremios y comunidades mapuches.

26-mar-2018
Ante el creciente consumo de huevos ecológicos o de “gallinas felices”, valorizadas por su composición nutritiva y beneficios para la salud, un grupo de investigadores del Centro de Estudios de la Universidad de Santiago, ofreció a comunidades Huilliche de Río Negro innovar en el mercado con la producción no industrial y ecológica de huevos azules enriquecidos con ácidos grasos omega-3 y antioxidantes.

26-mar-2018
Los socios de Gea Enzymes, todos menores de 26 años, desarrollaron la primera plataforma de inteligencia artificial que permite diseñar enzimas y proteínas que tengan una aplicación industrial, para acelerar procesos en áreas como los alimentos y farmacéuticas.

26-mar-2018
La actividad se enmarcó en el desarrollo del proyecto FONDEF de variedades tolerantes a frío y resistentes a herbicidas ejecutado por INIA, con financiamiento del Fondo de Fomento al Desarrollo Científico y Tecnológico, FONDEF, y el co-financiamiento de INIA, Tucapel S.A., Carozzi, S.A. y BASF de Chile S.A.

23-mar-2018
Magallanes, como muchas otras regiones del país, pero sobre to- do en cuanto zona extrema, requiere que las nuevas autoridades y jefaturas miren mucho más allá de los próximos cuatro años de gobierno.

23-mar-2018
Como parte de su interés por aportar al desarrollo de la innovación y emprendimiento en el país, la Universidad Tecnológica de Chile INACAP inauguró hoy, en su Sede Santiago Sur, un moderno fab el cual se integra a la red de laboratorios de fabricación y prototipaje existente en todas las Sedes de la Institución en Chile. Esta red posibilitará la creación y el desarrollo de soluciones y proyectos orientados a la innovación y el emprendimiento posibilitando una red de trabajo integrada a nivel nacional.

23-mar-2018
Quitar el polvo o algunas manchas –producto de la acción de pesticidas– es mucho más rápido y sencillo gracias a esta máquina, prevista para ser empleada por pequeños y medianos agricultores para mejorar la apariencia del producto.

22-mar-2018
El capital apunta a participar en al menos 15 startups de base tecnológica en los próximos tres años.

22-mar-2018
La alimentación saludable se ha convertido en una tendencia global que está generando una creciente demanda de alimentos inocuos, naturales y capaces de contribuir a reducir el riesgo de enfermedades. El sector de alimentos es estratégico para la economía chilena, con incidencia en el conjunto de la sociedad y con un efecto tractor para el resto de actividades productivas y económicas.

21-mar-2018
El gerente agrícola de Viña Undurraga, Francisco Valdivieso, llamó poderosamente la atención en la última Conferencia & Exhibición de Redagrícola con su planteamiento sobre las innovaciones que parecen estar “digitalizando” el campo. Plantea que, si los monitoreos pretenden lograr algo más que mapas coloridos para adornar las paredes e impresionar a los visitantes, deben estar respaldados por sistemas de gestión. En su caso la medición de vigor vegetacional y el mapeo de suelos son ya prácticas incorporadas, pero solo porque han demostrado que aportan en la relación costo/beneficio. Otras innovaciones, asegura, tienen que recorrer camino para comprobar su utilidad.

20-mar-2018
Un equipo de expertos de la Universidad de Chile está trabajando en un Proyecto ovino cuyo objetivo general es favorecer el desarrollo del sector ovino regional con especial énfasis en el territorio del Secano, consolidando un producto Premium con identidad territorial, bajo una institucionalidad pública-privada capaz de darle gobernabilidad y sostenibilidad en el tiempo. En lo concreto se busca posicionar al Cordero del Secano como un producto de calidad superior ligado a un territorio particular (Secano) reconocible en todo el país y que incentive la inversión en la zona.

20-mar-2018
Según un estudio de Mintel de diciembre de 2017, los consumidores se preocupan cada día más por aspectos como la sostenibilidad en los productos cárnicos.

19-mar-2018
El despertar de la fruticultura en la zona sur ya no es sólo una quimera. Por ejemplo, la superficie destinada a frutales en La Araucanía presenta un crecimiento de un 182% en 10 años. Según los datos del último catastro frutícola elaborado por el Centro de Información de Recursos Naturales (Ciren) entre el año 2012 y 2016 las plantaciones se incrementaron un 44% en la región.

19-mar-2018
En el estudio titulado “Coordinated species importation policies are needed to reduce serious invasions globally: The case of alien bumblebees in South America”, publicado recientemente en el Journal of Aplied Ecology, se da cuenta de cómo la introducción del abejorro europeo Bombus terrestris está amenazando con exterminar al abejorro colorado Bombus dahlbomii, especie nativa de Argentina y Chile que se encuentra en peligro de extinción. La investigación advierte graves consecuencias ambientales, políticas y económicas causadas por la importación intencional de insectos exóticos, lo que ha sido impulsado durante años por las políticas públicas nacionales.

19-mar-2018
Las abejas están desapareciendo de nuestro planeta, y el trabajo que realizan es algo demasiado importante como para que permitamos que eso ocurra.

16-mar-2018
Las ideas de innovación pueden brotar desde el interior de la propia firma, a través del esfuerzo creativo de personas individuales y grupos, y también del exterior. A continuación vamos a analizar ambos casos.

15-mar-2018
El cultivo de castaños durante los últimos años ha mostrado un destacable crecimiento en Chile. Si bien la región del Bío Bío, principalmente la Provincia de Ñuble, sigue liderando la producción, la zona sur tiene grandes posibilidades de sumarse a este boom productivo.

15-mar-2018
Melipilla.- Las primeras harinas “gluten free” elaboradas en Chile, fueron lanzadas oficialmente al mercado ayer en Melipilla, donde la joven empresa “Cosecha Justa” recientemente inauguró el primer molino del país dedicado exclusivamente a la molienda de granos sin gluten.

15-mar-2018
El creciente rol de China como productor e importador, el auge de las frutas congeladas y el apetito por lo orgánico son algunos de los cambios más relevantes que detecta un informe internacional de Rabobank centrado en la última década, donde la producción mundial crece 25% y Chile se destaca como uno de los principales exportadores, con gran potencial en los superalimentos.

14-mar-2018
Ejemplares fueron traídos desde Europa y están provocando graves impactos al medio ambiente, afectando a las abejas melíferas nativas y también a algunos cultivos.

14-mar-2018
Los alumnos de agronomía de la Universidad de Concepción participaron de una gira por la Región de Coquimbo con el objetivo de conocer la realidad agrícola local.

13-mar-2018
Junto a representantes de las organizaciones campesinas, investigadores de centros de estudios especializados y directivos de entidades gubernamentales y organismos internacionales, INDAP presentó el Manual de Transición Agroecológica para la Agricultura Familiar Campesina (AFC). Esta publicación, que forma parte de la Serie de Manuales y Cursos de la institución, aborda en nueve capítulos las etapas para avanzar desde una agricultura tradicional hacia prácticas agroecológicas y ambientalmente sustentables.

12-mar-2018
A través de un proyecto denominado “Habilitación de productores hortícolas de la región Metropolitana para la elaboración de productos de IV gama”, un grupo de investigadores de la Universidad de Santiago (Usach) logró ampliar y fomentar la agricultura familiar en la región.

12-mar-2018
Hace varias semanas escribí un post sobre las medidas adoptadas para mejorar la eficiencia en los canales de riego y las actuaciones que se han llevado a cabo en los últimos años en España para mejorar el uso del agua en estas infraestructuras. A partir de esta publicación y gracias a la ceremonia de entrega de los premios #Iagua2017, celebrada a finales del pasado mes de diciembre en Madrid, conocí a un responsable de la empresa Rubicon Water, especializada en mejoras de las infraestructuras de regadío y de abastecimiento, explicándome datos que me parecieron muy interesantes. Cuando el debate en España se centra en soluciones para aumentar la disponibilidad del agua, el presente post pretende evidenciar que aún hay camino por recorrer con otras soluciones que nos permitirían ser más eficientes.

09-mar-2018
Concluye con éxito el último proyecto de excelencia del grupo HIBRO AGR-170, adscrito al ceiA3 de la Universidad de Córdoba, diseñado para alargar la vida comercial y la calidad sanitaria de los productos de consumo diario

09-mar-2018
Numerosas hectáreas de frutos rojos han sido arrasadas en Huelva por los tornados y las fuertes rachas de viento el domingo por la tarde. Las zonas más afectadas, situadas en la frontera con Portugal, han sido Ayamonte, Isla Cristina, Cartaya, Lepe y Trigueros, donde según Freshuelva han sido derribados invernaderos y se han producido daños en estructuras, además de haberse perdido parte de la producción directamente. El sector ya viene de sufrir condiciones meteorológicas adversas, con abundantes lluvias y vientos fuertes desde la semana pasada, y que no parece que vayan a dar tregua durante al menos una semana más.

09-mar-2018
Este año se verá a más consumidores cuestionando sus prioridades y decisiones de compra, reveló un informe de Euromonitor Internacional.

08-mar-2018
El Instituto Interamericano de Cooperación para la Agricultura (IICA) ha publicado el documento "Innovaciones institucionales en cooperativas agropecuarias en la Argentina" con el objetivo de aportar conocimientos sobre la innovación institucional en cooperativas agropecuarias en la República Argentina, basado en el análisis de casos concretos.

07-mar-2018
Las máquinas que se comunican sin interferencia humana, intercambiando datos a través de la web, ya son una realidad en el campo. Y, en el futuro, los equipos agrícolas van a tener más y más sensores conectados a Internet. La inteligencia artificial aplicada a la agricultura puede mejorar los procesos de producción y apoyar la toma de decisiones de los agricultores, reduciendo los costos y generando un mayor rendimiento.

06-mar-2018
Una asociación entre Embrapa y Benson Hill Biosystems (BHB), una compañía con sede en Carolina del Norte, Estados Unidos, tiene la intención de utilizar técnicas de vanguardia para acelerar el desarrollo de las plantas y ampliar la variabilidad genética de los cultivos comerciales.

06-mar-2018
Se cultivan desde fresas hasta lechugas, albahaca y alubias.

06-mar-2018
A mediados del 2017, la Presidenta Michelle Bachelet anunció la inclusión de contenidos sobre cambio climático en la malla curricular escolar. En esta primera etapa, el Ministerio del Medio Ambiente ha trabajado con las bases curriculares de tercero y cuarto medio, incorporando el tema en la asignatura “Formación Ciudadana”.

06-mar-2018
En la terraza del Edificio Administrativo de Utadeo se construye el primer apiario peri urbano con estructura en guadua, que albergará a cerca de medio millón de abejas, distribuidas en diez colmenas. Las investigaciones que se desarrollarán en la Universidad se centrarán en la producción de cápsulas de polen para el consumo humano.

05-mar-2018
La oveja merino, originaria de España, es una de las razas más antiguas del mundo y su lana una de las más preciadas del planeta, pero descuidada por la producción industrial. Por esta razón, un grupo de tejedoras y productores de ovino de la zona centro sur de Chile busca rescatarla del olvido.

05-mar-2018
Con foco en el crecimiento internacional y en el lanzamiento de nuevos productos, fundadores de compañías como NotCo y Yerka revelan sus planes para este año. Aportes de capital, ingreso a otros mercados y desarrollo de app son parte de su estrategia de consolidación.

05-mar-2018
El catálogo se suma a otros soportes que buscan aumentar mercados para la Agricultura Familiar Campesina, como la Red de Tiendas Mundo Rural (Mundo Agropecuario).

02-mar-2018
El plan, presentado en el marco del SIA, pretende la producción agrícola sostenible y el impulso de la bioeconomía en la sociedad.

01-mar-2018
Trabajo desarrollado por los investigadores: Fernán Silva Labbe - Ingeniero Agrónomo del Servicio Agrícola y Ganadero Coyhaique, Jaime Salinas Sanhueza - Ingeniero Forestal del Instituto Forestal Coyhaique e Iván Rodríguez Huerta - Ingeniero Forestal del Servicio Agrícola y Ganadero Coyhaique.

01-mar-2018
Hongusto: Innovación social en torno a los hongos silvestres y cultivados en Aysén es el nombre del proyecto y libro que se presentará el día viernes 16 de marzo a las 17:30 Hrs en el Centro Universitario de la Patagonia.

19-feb-2018
Las exigencias de fumigación para los blueberries orgánicos que ingresan a EE.UU. provenientes de OHiggins, Maule y Biobío, para controlar la Lobesia botrana empujan el alza en la zona sur.* En un año, las hectáreas certificadas se duplicaron, pasando de 1.400 ha a más de 3.200 a nivel nacional.

19-feb-2018
Esta Casa de Estudios lidera la Plataforma de Innovación en Envases y Embalajes para Alimentos, que tiene por objetivo estructurar un ecosistema abierto y colaborativo a nivel nacional. Este proyecto, financiado por la Gerencia de capacidades tecnológicas de CORFO; área de programas tecnológicos estratégicos, pondrá a disposición de la industria agroalimentaria los conocimientos científicos-tecnológicos e infraestructura necesaria para incrementar la diversificación y sofisticación de sus productos, con especial énfasis en la transferencia de tecnologías innovadoras y en la formación de recursos humanos calificados en esta materia.

19-feb-2018
Es el primer día de campo de cinco que se realizarán durante este año, ocasión en que los asistentes conocen las nuevas variedades de hortalizas y las tecnologías utilizadas.

19-feb-2018
El Centro Tecnológico dio a conocer esta innovación en una jornada exclusiva para semilleros.

12-feb-2018
Con la finalidad de combatir la problemática de las emisiones de CO2 en la atmósfera, el cambio climático, calentamiento global y el efecto invernadero, inició el proyecto del Centro de Innovación en Insumos para Bioenergéticos y Coproductos (CIBIOC) que tendrá sede en el Campo Experimental Zacatepec, Morelos, del Instituto Nacional de Investigaciones Forestales, Agrícolas y Pecuarias (INIFAP), así lo destacó el encargado del Despacho de los Asuntos de la Dirección del Instituto.

12-feb-2018
Los Ministerios del Medio Ambiente, Ministerio de Agricultura y la Agencia de Cooperación Internacional de Chile (AGCI), firmaron un acuerdo del proyecto “Mejoramiento de resiliencia al cambio climático de la pequeña agricultura en la Región de O’Higgins”.

05-feb-2018
Una investigación del Departamento de Ciencias Agrarias y del Medio Natural de la Universitat Jaume I (UJI) de Castellón, España, ha identificado genes de cítricos que la biotecnología podría mejorar para hacer frente al cambio climático.

31-ene-2018
Región de Coquimbo, enero de 2018.- Entre las regiones de Atacama y Coquimbo se encuentran los valles donde se produce la totalidad de las diez mil ha. de vides plantadas para producir pisco con denominación de origen. La superficie está formada por 5 variedades tradicionales: Moscatel de Alejandría, Moscatel Rosada, Moscatel de Austria, Pedro Jiménez y Torontel. Sin embargo, las variedades autorizadas para la producción de Pisco —que responde a la denominación de origen— son trece. “Todos los destilados que se produzcan fuera de estos valles no son pisco, son aguardiente”, explica Francisca Martínez, representante de la Fundación para la Innovación Agraria (FIA) en la zona norte del país, agencia del Ministerio de Agricultura que impulsó esta parte de la iniciativa.

08-ene-2018
Incubadora se ubica como líder en la adjudicación de proyectos VIU de Fondef Conicyt. La idea es continuar creando empresas de base tecnológica.

22-dic-2017
Inaugurada en 1975, esta empresa se ha preocupado de entregar productos innovadores con el mejor servicio, lo que le ha permitido consolidarse en el mercado nacional a través del tiempo.

29-mar-2019
La Universidad del Claustro de Sor Juana y el Consejo Mexicano Vitivinícola, lanzan su curso en línea gratuito MOOC Vinos mexicanos: historia, actualidad y perspectivas, a través de la plataforma MéxicoX, que se desarrollará del 29 de abril al 9 de junio próximo, por lo que actualmente se encuentran las inscripciones abiertas.

28-mar-2019
Verduras de fábrica, carne de laboratorio: nuevas tecnologías revolucionan la agricultura. Y podrían ayudar a alimentar a los habitantes de las megaciudades. Del tema se habló en la Cumbre Global del Alimento, en Múnich. La empresa muniquesa Agrilution tiene una idea diferente sobre la agricultura urbana. Los maceteros en el balcón son cosa del pasado.

26-mar-2019
El recién inaugurado Nodo Sur CeTA-UFRO está orientado principalmente a Pymes y emprendedores que deseen desarrollar ingredientes saludables, alimentos procesados y packaging.

25-mar-2019
Faisal Mohammed Al Shimmari cultiva la tierra en unas de las condiciones más extremas del mundo, en Al Ain, un oasis en el desierto de Emiratos Árabes Unidos (EAU), donde las temperaturas pueden alcanzar los 50 °C.

25-abr-2018
Los investigadores lograron reducir los costes y contribuyen al tratamiento de residuos agrícolas.

24-abr-2018
Se instalarán en edificaciones para cultivar verduras a escala industrial.

23-abr-2018
Néctar de maqui o papel que germina son algunos de los productos que han ganado los Premios Latinoamérica Verde, el concurso ecológico más grande de la región que inició su versión 2018.

23-abr-2018
Según datos del Comité de Arándanos de Chile, la pudrición gris o botrytis, ha causado importantes pérdidas por concepto de exportación, siendo por lejos el de mayor impacto negativo en la industria.

22-abr-2018
El 15% de la población de Monte Patria ha dejado la ciudad por razones climáticas, los primeros migrantes de este tipo certificados en Chile, según un estudio de la ONU. Como ellos, otros habitantes del país están dejando sus tierras por el implacable avance del cambio climático, que hoy cobra relevancia en el marco de la celebración del 48° Día de la Tierra.

22-abr-2018
Así lo indica el estudio “Chile 3D 2018” que será dado a conocer la próxima semana. Chilenos también están inquietos por el cambio climático y los perros callejeros.

21-abr-2018
La primera “Ruta del arroz chileno” realizaron este miércoles en San Carlos un grupo de chefs, productores, profesionales del rubro y autoridades, convocados por Arrocera Santa Marta y la Federación de Arroceros de Chile (Fedearroz), jornada en la que recorrieron el proceso del cereal, desde la cosecha hasta la mesa.

20-abr-2018
European farmers should invest in post-2020 agriculture as it will be less bureaucratic, more focused on “technology breakthroughs” and will improve their standard of living, EU Commissioner Phil Hogan told EURACTIV.com.

20-abr-2018
La protección de las fuentes de agua, el uso eficiente del recurso, la gestión de la información y divulgación y la gestión de riesgos, son las cuatro acciones que llevarán a cabo.

20-abr-2018
La FAO orienta sobre como aprovechar al máximo las innovaciones y evitar el desperdicio de agua.

19-abr-2018
Barely six years old, the EU’s Bioeconomy Strategy, currently under revision, is slowly but surely propagating green shoots of sustainable economic recovery in innumerable and unexpected ways, writes Joanna Dupont.

19-abr-2018
Investigadores recurren a la simbiosis al agregar bacterias y hongos provenientes de plantas del continente blanco con tolerancia ambiental únicas en el mundo. Árboles amenazados de desaparecer, como el Ruil, lograron aumentar sus posibilidades de vida en un 40% respecto a los no inoculados.

19-abr-2018
Especialistas del INTA pueden estimar la evapotranspiración real de los cultivos y, al compararlo con datos históricos, confirmar o desestimar el estrés hídrico. Herramienta clave para la declaración de emergencia agropecuaria en tres provincias.

18-abr-2018
La tendencia de la agricultura en el mundo es la producción orgánica de alimentos. Gran cantidad de productores tradicionales están pasando de la utilización de químicos dañinos para el medio ambiente a procesos y mecanismos naturales, biodegradables y de bajo impacto para los ecosistemas. Sin embargo, asumir un desafío como este implica esfuerzos que no siempre son considerados al momento de tomar la decisión de ser orgánicos.

18-abr-2018
Energía, agua, minería, smart cities, big data e internet of things (IoT) son los principales sectores que pueden beneficiarse con Clin, el reciente fondo de capital de riesgo presentado por ChileGlobal Ventures, la plataforma de emprendimiento de la Fundación Chile.

18-abr-2018
ALIMENTO. Hoy en San Carlos se realizará la Primera Ruta del Arroz Chileno, actividad que busca potenciar la agroindustria local.

18-abr-2018
Desde el 17 de abril hasta el 11 de mayo, podrán postular a esta convocatoria todos los emprendimientos que provengan de procesos de investigación aplicada de cualquier industria y que aspiren a una próxima salida al mercado.

16-abr-2018
El dispositivo opera online y sólo tienen acceso los integrantes de la mesa de prevención de incendios forestales.

16-abr-2018
Lo anunció su Presidente, Roberto Angelini en el lanzamiento de los Concursos 2018 de la entidad.

15-abr-2018
Formar una empresa y ser tu propio jefe es muy tentador, sobre todo para los trabajadores actuales que pertenecen a la “Generación Millennials”, libre de esquemas y sin miedo a buscar nuevos horizontes. Una especialista explica por qué hoy todos desean ser emprendedores y entrega algunas recomendaciones para atreverse.

14-abr-2018
Gracias al apoyo de Corfo, seis agricultores se asociaron y crearon "Agroplants", logrando consolidar su apuesta y así dar trato justo y especial a la economía a pequeña escala de la zona.

13-abr-2018
“El potencial genético, la sanidad y el vigor de la semilla nos va a definir si un cultivo o una actividad agronómica es productiva o no, si va a ser rentable o no, si un agricultor va a salir adelante o no va a salir adelante, todo eso empieza desde la semilla y por eso hay un valor agronómico que debe estar reflejado en una Política Nacional de Semilla”, Dr. Luis Felipe Araúz, ministro de Agricultura y Ganadería.

12-abr-2018
El documento señala que al 2016 estas plataformas habían levantado unos US$180 millones en el país.

12-abr-2018
Es un mercado de poco volumen, pero de alto valor agregado, que presenta un alza de ventas constante en los últimos ocho años. Rúcula, berro, kale, brócoli, tomate cherry y un amplio surtido de lechugas conforman una oferta de cuarta gama, en la cual la conveniencia y los nuevos sabores marcan la tendencia.

12-abr-2018
El 19 de marzo se abrieron las inscripciones, se llevarán a cabo el 10 de septiembre en Singapur.

12-abr-2018
A través de un proyecto ejecutado por Curimapu Vegetables Seeds SpA, con el apoyo del Programa de Desarrollo de Proveedores (PDP) de CORFO, más de 20 pequeñas y medianas empresas hortícolas, lograron elevar su competitividad y establecer redes de colaboración.

11-abr-2018
Fortaleciendo las capacidades de emprendimiento e innovación existentes en el ecosistema regional, se presenta en Temuco el proyecto Impulsa Araucanía, que busca generar un beneficio directo a quienes estén desarrollando proyectos o tienen la intención de seguir ese camino.

10-abr-2018
La iniciativa municipal busca que los vecinos se perfeccionen en temas preventivos para sus animales y hortalizas en la temporada invernal.

10-abr-2018
En la Universidad Católica del Norte de Coquimbo se dio a conocer la versión 2018 del concurso de innovación escolar SaviaLab edición regional.

09-abr-2018
Conclusiones de Proyecto FIC de la Universidad Mayor. Tras dos años de experimentación con el cultivo en la región, se dará continuidad al trabajo alcanzado por medio de este proyecto mediante el desarrollo de unidades de comercialización del alforfón y sus subproductos.

09-abr-2018
Este diplomado busca que los participantes conozcan y comprendan los procesos productivos de su elaboración y los manejos que están involucrados para conseguir una alta gama en los vinos, necesarios para el manejo de los viñedos, como los utilizados en la producción, elaboración y conservación del mismo.

09-abr-2018
Veterinarios, agricultores, estudiantes de postgrado, establecimientos ganaderos, investigadores y científicos tienen hasta el 25 de junio para postular con sus ideas innovadoras para mejorar el bienestar animal en el concurso global de Bayer “Care4Cattle”.

09-abr-2018
Proyecto de investigación y transferencia es financiado por el Fondo de Innovación para la Competitividad (FIC) de la Región del Maule con la participación de las empresas I+D Agroecología Ltda. y Nutrifert, el Prodesal de la Municipalidad de Maule y la ejecución del Instituto de Investigaciones Agropecuarias (INIA Quilamapu) de Chillán.

09-abr-2018
Hasta el lunes 16 de abril a las 15:00 horas, se amplió el plazo de postulación para los programas del Comité de Desarrollo Productivo Regional, entidad que reúne el trabajo de Corfo y Sercotec en Antofagasta. Se trata de los instrumentos “Capital Semilla” y “Abeja Emprende” y el programa “Crece, Fondo de Desarrollo de Negocios”, líneas de financiamiento disponibles para poner en marcha un proyecto de negocio, y potenciar el crecimiento de una pequeña empresa.

07-abr-2018
Hoy existe un gran debate sobre los beneficios, características y diferencias entre la proteína animal y vegetal.

06-abr-2018
Los consumidores alemanes presentan una creciente demanda de alimentos orgánicos, como lo confirma el aumento de un 6% en 2017 del gasto de los hogares en productos orgánicos.

06-abr-2018
El aumento en la frecuencia de olas de calor, sequías y eventos de precipitaciones intensas, que se prevé para los próximos 50 años, pondrá en riesgo la seguridad alimentaria. Especialistas del INTA estudian cómo aumentar la resiliencia de los principales cultivos.

06-abr-2018
La propuesta será financiada por la Comisión Nacional Científica y Tecnológica (Conicyt) durante tres años y generará una sólida red de datos climáticos y meteorológicos que aportarán valiosa información sobre el Cambio Global y sus consecuencias en la región de Aysén.

05-abr-2018
El proyecto tecnológico fue desarrollado en un plazo de tres años, licenciado en 2017, siendo el principal objetivo crear mallas con técnicas foto-selectivas específicas para condiciones climáticas locales (Universidad de Concepción).

05-abr-2018
Colombia, uno de los 17 países con mayor biodiversidad en el mundo, albergó estos días una cumbre que dio a conocer el estado global de la cuestión. El deterioro de este bien común también impacta la región.

04-abr-2018
Futuros ingenieros aportan al rescate y preservación del patrimonio vitivinícola ancestral de las comunidades campesinas en Guarilihue.

04-abr-2018
Este certamen, organizado por la Facultad de Ingeniería, a través del Proyecto Nueva Ingeniería 2030, tiene como objetivo desarrollar habilidades de Innovación, fomentar la interdisciplina y generar vínculos con el medio. En la práctica, se trata de un torneo formativo de innovación que utiliza una metodología colaborativa centrada en usuarios, aplicando herramientas que permiten definir problemas, idear soluciones y crear prototipos a través de charlas, talleres, salidas a terreno y presentaciones orales. Para esta nueva versión, la Unidad Mayor desarrolló alianzas con Transantiago y, a la vez, mantiene el compromiso con el territorio a través del municipio de Cerro Navia, el Centro de Trastorno del Movimiento y la Fundación para la Innovación Agraria. En la imagen, los ganadores de la versión 2017.

03-abr-2018
En un moderno invernadero de mil metros cuadrados, que funciona con energía renovable de su sistema energético fotovoltaico y se abastece con agua purificada por osmosis inversa, los 11 agricultores que integran la Cooperativa Hidropónica de Quillagua producen al mes más de 4 mil sabrosas y frescas lechugas hidropónicas.

03-abr-2018
Años de sequía, años de inundaciones, cambio climático. Todo afecta a la capacidad hídrica de un país y en este caso, a la agricultura.

03-abr-2018
Del 2 al 5 de agosto en Montevideo, Uruguay, se llevará a cabo el XIII Congreso Latinoamericano de Apicultura, organizado por la Federación Internacional Latinoamericana de Apicultura, FILAPI. El Congreso tendrá un carácter gremial, técnico, científico y comercial.

02-abr-2018
Detectados focos de este insecto en Brasil, Argentina declara el alerta sanitario respecto a esta plaga, fundado en el riesgo de introducción que implica su presencia en el país limítrofe.

02-abr-2018
Movidos por su interés de ayudar a la conservación ecológica y tras adjudicarse el concurso Despega Usach 2017, un grupo de egresados de nuestro Plantel ideó novedosos materiales biodegradables con el fin de crear envases desechables y sostenibles. Cabe destacar que actualmente cerca de 3 mil 400 millones de bolsas plásticas son utilizadas cada año en Chile, de las cuales un 90% termina vertido en espacios públicos.

02-abr-2018
Investigadores iberoamericanos se reunieron en Santiago para compartir los resultados de sus estudios más recientes. Destacó la presencia de representantes de la industria, como charlistas y asistiendo a las conferencias para conocer los adelantos que pudieran resolver sus desafíos actuales. Entre los aspectos más tratados en las presentaciones se encuentra el efecto de diferentes estrés en precosecha, el boom del mínimo proceso, la búsqueda de posibilidades de plantas nativas, y las respuestas para garantizar a los consumidores los atributos de los alimentos que ellos esperan.

02-abr-2018
Actualmente la producción de arándanos es un buen negocio en la medida que el rendimiento de un huerto en promedio supere las 10 ton/ha. Las tecnologías de regulación de carga frutal, nutrición racional y riego, son el sostén de alta productividad, y aseguran además una calidad y condición de cosecha capaz de soportar largos períodos de viaje, manteniendo la calidad del producto apetecido por los consumidores. Desde el punto de vista de la nutrición, alcanzar los niveles adecuados de suministro de nutrientes en el suelo y al mismo tiempo mantener relaciones óptimas entre ellos, es la clave para obtener alta productividad en huertos de arándanos. A pesar de ello, es uno de los factores de manejo, que menos importancia le ha otorgado el productor. No es posible elevar la productividad del cultivo, cuando los niveles óptimos nutrientes en el suelo, no han sido alcanzados.

02-abr-2018
Sistema conocido como SRI es principalmente usado en África y está siendo probado y adaptado por investigadores del Instituto de Investigaciones Agropecuarias, INIA, a las condiciones de suelo y clima chilenos.

28-mar-2018
El programa de Becas Chile, que permite estudiar en el exterior, priorizará, además, el área hídrica y digital.

28-mar-2018
Se pretende mejorar el nivel de vida de los campesinos asentados dentro del ámbito de la Comunidad Peruana, a través de la incorporación tecnológica y la diversificación de cultivos.

27-mar-2018
La medición permite analizar los efectos que han tenido en el agro las políticas públicas, así como los programas de transferencia tecnológica y asistencia técnica. El estudio, adelantado por el Grupo de Investigación RAET, indica que tan solo el 5% de las empresas agrícolas es líder en innovación.

26-mar-2018
Generar y adaptar conocimientos científicos y tecnológicos que sirvan de base para el manejo sustentable de los recursos naturales, con énfasis en el recurso agua y suelo, teniendo como base las demandas de las cadenas del sector agropecuario y forestal del país, considerando a la cuenca hidrológica como unidad de planeación y desarrollo, es la esencia principal del Centro Nacional de Investigación Disciplinaria en Relación Agua, Suelo, Planta, Atmósfera (CENID RASPA).

16-mar-2018
El carbono orgánico del suelo (COS) constituye la base de la salud del suelo, la fertilidad y la producción de alimentos. Un suelo sano con una cantidad ideal de COS (el principal componente de la materia orgánica del suelo) puede proporcionar condiciones óptimas de crecimiento de las plantas, ciclos de nutrientes funcionales, e infiltración y almacenamiento efectivos de agua. Los suelos agrícolas se encuentran entre los mayores y acimientos de carbono del planeta y tienen un potencial de aumento del secuestro de carbono, y proporcionan así una manera prospectiva de mitigar la creciente concentración atmosférica de dióxido de carbono

30-ene-2018
Cinco productores de la región probarán suerte en el extranjero durante las próximas semanas gracias al proyecto ejecutado por la Universidad Central.

29-ene-2018
Compilar y visualizar información como apoyo para la toma de decisiones en el Sistema Nacional de Innovación y Emprendimiento es el principal objetivo del Observatorio CTIE, elaborado por el ministerio de Economía a través de una plataforma digital que permite monitorear y ayudar a la evaluación de este tipo de políticas públicas.

26-ene-2018
El presidente del Comité de Hortalizas, Cristián Muñoz y Agustín Aljaro, Asesor en hortalizas analizan el sector.

05-ene-2018
El resultado de esto será la transferencia de activos biotecnológicos al sector agrícola.

28-may-2019
Los meteorólogos son científicos de la atmósfera de la tierra, usan observaciones y modelos informáticos para comprender y predecir el comportamiento del clima, pero muchos de ellos se preguntan: ¿qué tan útil puede ser la información que generamos los meteorólogos para un agricultor de escala familiar? Con el propósito de conocer experiencias exitosas de productores empoderados en el uso de información climática, e instituciones orientadas al usuario de información, una comisión de funcionarios del servicio climático de Honduras e investigadores de CIAT-Honduras participaron de un viaje de intercambio a comunidades e instituciones en Colombia.

27-may-2019
La alimentación complementaria mitiga el problema, debido a que mantiene la población de colonias de abejas hasta el nuevo ciclo de floración. La sustitución puede ser de dos tipos: energética o proteica.

20-may-2019
Existe un lugar en Utadeo en el que crear, interactuar, explorar, resolver problemas y divertirse son sinónimos. Se trata de Tadeo Lab, un espacio de experimentación en arte, ciencia y tecnología que, desde el 2014, se ha convertido en columna vertebral de los procesos de innovación pedagógica y en el centro de los diálogos interdisciplinares en la Universidad. Allí el foco es la participación ciudadana a través de la vinculación de los estudiantes con las comunidades, quienes desarrollan proyectos reales de alta incidencia.

20-may-2019
El equipo de Sanidad Vegetal del INTA Alto Valle obtuvo la Mención Honorífica en la Categoría Innovación Tecnológica en el Concurso Internacional Innovagro 2019, cuyo acto de premiación se celebrará el 14 de junio en España.

16-may-2019
¿Cómo innovar y asociarse con Embrapa? Mucha gente no sabe, pero ya es posible trabajar juntos desde la fase de elaboración de ideas hasta la explotación comercial de un producto o servicio. Embrapa, empresa pública que cumplió 46 años en abril, ya es referencia mundial en investigación y desarrollo y está cada vez más empeñada en incrementar su área de innovación. "Brasil tiene una alta producción baja producción científica y las innovaciones. Somos el país número 13 en el ranking con respecto a la producción de la ciencia y el país 76a en la innovación tecnológica", dijo José Manuel Cabral, Director General de Embrapa Recursos Genéticos y Biotecnología durante el "Papel de los socios en las innovaciones de Embrapa" conferencia celebrada el pasado martes (14) en la feria AgroBrasília 2019.

15-may-2019
Los cambios en el clima y el uso de la tierra pueden tener impactos irreversibles en la biodiversidad de los ecosistemas terrestres. Las consecuencias de estas amenazas para nuestros ecosistemas se entienden parcialmente.

13-may-2019
El instituto busca el desarrollo de proyectos integrales por regiones, que sean incluyentes y sustentables, y que fortalezcan las cadenas de valor en la producción del sector agroalimentario con el cuidado del medio ambiente.

10-may-2019
Desde el Medio Oriente y con una tradición que se remonta a alrededor de 3 mil años, abarcando diferentes culturas, continentes, y civilizaciones, el azafrán se ha transformado en el nuevo "Oro Rojo", tanto para para la cocina, el mundo de la salud y la cosmética.

29-may-2018
INIA, en conjunto con el Consorcio Biofrutales, se encuentra desarrollando un programa de mejoramiento genético de cerezos para obtener variedades de alto potencial comercial orientadas a la industria tradicional y para zonas más tempranas de producción.

29-may-2018
El premio tiene tres categorías que son: Innovación tecnológica, institucional y social, y se podrán postular hasta tres innovaciones, una por cada categoría.

28-may-2018
El aumento de dióxido de carbono en la atmósfera reducirá el valor nutricional del arroz, según una investigación liderada por la Universidad de Tokio (Japón).

25-may-2018
Para muchas personas, la tecnología agrícola comienza y termina con un tractor, pero la realidad está lejos de eso.

24-may-2018
El estudio lo llevará a cabo la Unidad de Endotelio del Ramón y Cajal.

24-may-2018
Al obtener el Sello de Origen, quedó registrada como una pieza única y se busca fomentar su valorización dentro de la comunidad. Conozca otros artículos y alimentos que cuentan con tal distinción y cómo es el proceso que se sigue.

23-may-2018
Startups de Chile, Argentina, Perú y Bolivia interesadas en desarrollar soluciones solares en la Región de Arica y Parinacota, con especial foco en agroindustria, comercio y desarrollo urbano -entre otras áreas- son los principales invitadas a participar de la convocatoria “La Fiebre del Sol 2”.

22-may-2018
Un estudio reveló que limitar el calentamiento a 1,5°C en vez de los 2°C actuales salvaría a la gran mayoría de las especies del cambio climático, incluyendo numerosos tipos de plantas y animales.

22-may-2018
Coyhaique-. En la región de Aysén se están realizando dos talleres de difusión de buenas prácticas de recolección y propagación de los recursos del bosque, con una muy buena convocatoria y participación de recolectoras, recolectores y extensionistas de la región. Estos encuentros fueron organizados por la Fundación para la Innovación Agraria (FIA) con el apoyo de la cooperativa Calahuala.

21-may-2018
Convocado por su Presidente, Sebastián Monckeberg y su Vice Presidente William Burdus, se constituyó en Chilealimentos el Comité Maqui de Chile con el fin de desarrollar todo el potencial que este producto tiene para el país en los próximos años.

21-may-2018
En Rancagua se realizó el primer mercado de hortalizas 2018, ocasión en que nueve productores de hortalizas de especialidad del Programa Transforma O'Higgins HortiCrece, apoyado por Corfo expusieron sus productos al público presente y además vendieron las hortalizas que ellos cosechan.

18-may-2018
En la instancia, se dio a conocer la cuenta anual con los avances en temas de innovación, transferencia tecnológica y patentamiento. Además, se reconocieron a distintas facultades y académicos que han realizado una labor destacada en estos temas.

18-may-2018
Es una metodología de crianza y liberación masiva del ácaro fitófago “Neosiulus californus”.

18-may-2018
“Operaciones y aprendizaje avanzado en Bancos de Germoplasma” (GOAL, por sus siglas en inglés) se denomina el taller que reúne a especialistas en investigación agrícola provenientes de trece países de América Latina, entre ellos Chile.

16-may-2018
Tiene efectos protectores frente al hongo que pudre la raíz de los árboles de palta.

16-may-2018
Tras recibir 238 investigaciones postulantes este año, Brain Chile, programa de aceleración para proyectos de base científico-tecnológica, anunció a sus 36 mejores proyectos de esta versión, entre los que están cuatro innovaciones ganadoras y potenciadas por los concursos de Fundación Copec-UC: Simulmedic, FishExtend, Producción sustentable de ingredientes cosméticos, y Tratamiento preventivo contra Loque Americano y un nuevo concepto en reciclaje de RIL de Acicultura.

16-may-2018
Big Data, Internet de las cosas y Machine Learning son tecnologías innovadoras clave para orientar al productor hacia decisiones estratégicas que le permitan enfrentar los desafíos que plantea la agricultura del futuro.

15-may-2018
Impulsada por el Instituto de Investigaciones Agropecuarias, INIA, esta Feria busca mostrar innovación, tecnología de punta, experiencias y generar negocios junto a las empresas de Control Biológico más importantes del país.

13-may-2018
Iniciativa se enmarca en el programa “Fortalecimiento Tecnológico y Comercial de Recolectores de Productos No Madereros en la Región del Biobío”, financiado por el Gobierno Regional con recursos del Fondo Nacional de Desarrollo Regional (FNDR).

12-may-2018
Mira cómo la Red Innovación Chile potencia la dinámica colaborativa.

10-may-2018
Dice James Robinson, uno de los autores de "Por qué fracasan los países". Australia invirtió mucho en educación y exporta el expertise en minería, pero no se ven ingenieros chilenos en Kinshasa, dice.

09-may-2018
En el mes de mayo, parte del equipo técnico integrado por Natalia Olivares (INIA), José Montenegro (INIA) y Renzo de Kartzow (asesor externo), realizará los primeros viajes al territorio insular para realizar un levantamiento de la situación de las plagas sobre la base del monitoreo, toma de muestras y un reconocimiento de las especies más importantes que afectan a los cultivos.

09-may-2018
Con el objetivo de establecer estrategias de Gestión de la innovación, que sirvan como fuentes de desarrollo empresarial en todos los ámbitos de la empresas, además de crear organizaciones líderes, administradas por jóvenes emprendedores, se llevó a cabo el taller “Habilidades Blandas de Innovación para el Desarrollo Empresarial”, realizado en la Universidad Bluefields Indian and Caribbean Univesrity (BICU), ubicada en Bluefields, Región Autónoma de la Costa Caribe Sur.

08-may-2018
Informar sobre plagas, programar tareas y optimizar el uso del agua de riego son algunas de las funciones que cumple el primer asistente virtual para la agricultura creado por un grupo de jóvenes científicos de la región de O’Higgins, que buscan introducir la innovación y tecnología al sector frutícola.

07-may-2018
El cambio climático es uno de los principales desafíos que debe enfrentar la dinámica agrícola para que pueda ser eficiente y exitosa. De allí es que un grupo de profesionales encabezados por la incubadora AgroWine Lab desarrollan dinámicas estratégicas de innovación y desarrollo agropecuario.

07-may-2018
En los tubérculos, el corte o pelado y los daños mecánicos llevan a que se generen manchas pardas o negras. Con edición génica, investigadores del INTA logran modificar el gen de polifenol oxidasa, cuya enzima provoca la oxidación.

04-may-2018
Con apoyo del British Council, a través de su convocatoria REGIONAL INSTITUTIONAL SKILS DEVELOPMENT, el Subdepartamento de Información, monitoreo y Prevención (ExUnea) de la Subsecretaría de Agricultura ha dado inicio a la segunda etapa de su programa de fortalecimiento de capacidades locales para enfrentar sequía.

04-may-2018
SEREMI DE ECONOMÍA, IVÁN DAMINO: Autoridad hizo el llamado a postular al Capital Semilla Corfo 2018, cuyo plazo de cierre para el primer concurso es el próximo 23 de mayo.

04-may-2018
El Instituto de Promoción de la Carne Vacuna de Argentina (IPCVA) informó los resultados de las exportaciones de carne de vacuno argentinas, entre enero y marzo de 2018. En total, el país lleva exportadas 71.754 toneladas lo que supone una subida del 56,6% respecto a 2017.

03-may-2018
En una iniciativa de la Corporación Regional de Desarrollo Productivo, la Universidad Santo Tomás y ProChile, varios emprendedores de la región pudieron informarse sobre las condiciones y reglas para certificarse en comercio justo y comercializar sus productos en el extranjero con un valor agregado.

02-may-2018
Numerosos casos de progreso local, en los más diversos países, están abriendo una nueva perspectiva para analizar la relación que existe entre geografía y crecimiento, específicamente la identificación de los factores intangibles que permiten sostener un círculo virtuoso entre productividad e ingresos. Esto, a partir de la enorme dispersión que se observa entre ciudades que prosperan y aquellas que se rezagan, aunque compartan un pasado similar. Por ejemplo, Pittsburg y Detroit, o Los Angeles y San Francisco, con una realidad análoga hace algunas décadas, pero actualmente en trayectorias muy diferentes.

24-abr-2018
Fundación Cequa presentó seis iniciativas que cuentan con financiamiento de Conicyt, del Gobierno Regional, y aportes del ámbito privado, que refuerzan su compromiso con la ciencia y el desarrollo de Magallanes.

23-abr-2018
Normativa busca fortalecer el rol del Minam en la gestión y prevención del cambio climático, con la participación de otros ministerios y gobiernos regionales y locales.

20-abr-2018
Menos lluvias y cambios en la dieta nacional e internacional han afectado algunos productos típicos de la zona, como las uvas de mesa y las paltas.

18-abr-2018
La Convención Internacional de Protección Fitosanitaria aprueba normas sobre moscas de la fruta, tratamientos térmicos y químicos, vigilancia, y embalaje de madera.

17-abr-2018
El Instituto Interamericano de Cooperación para la Agricultura (IICA) es organismo hemisférico de promoción del desarrollo agropecuario. Su director general, Manuel Otero, visitó recientemente Chile y se reunió con el ministro de Agricultura Antonio Walker.

22-ene-2018
A la luz del Brexit, no cabe duda de que el futuro de la política agrícola de la UE dominará las discusiones en Bruselas en 2018. Pero la necesidad de innovación y la introducción de nuevas tecnologías en el sector provocará intensos debates y provocará fuertes reacciones de las ONG verdes.

31-may-2019
Se trata material biodegradable en base al elemento marino y pino radiata. Centro de Biotecnología de la Universidad de Concepción trabaja en la producción del elemento.

17-may-2019
AgroUrbana es la apuesta de dos profesionales que vienen del mundo de la energía renovable y que pretenden tener un producto consistente durante este año, y con un precio que no se verá afectado por vaivenes climáticos. Usan menos del 5% de agua que un cultivo tradicional, controlan las variables climáticas, usan tecnología LED, producen en un ciclo de un mes y en marzo tendrán su primera producción.

06-may-2019
“Dirección de Innovación para la Industria Regional” tiene como propósito generar instancias de innovación y desarrollo tecnológico enfocadas en fortalecer el enoturismo la Ruta y Vinos Cachapoal de la Región de O’Higgins.

29-jun-2018
La Oficina Regional para América Latina y el Caribe de la Organización de las Naciones Unidas para la Alimentación y la Agricultura (FAO) invita a todas las entidades con personalidad jurídica que trabajan en territorios rurales, a inscribir iniciativas innovadoras que actualmente se encuentren en ejecución y que estén orientadas al desarrollo rural sostenible.

27-jun-2018
Creación de vacunas, alimentos saludables que combatan la desnutrición y la obesidad; y la lucha contra el cambio climático, fueron algunos de los temas de interés mutuo.

26-jun-2018
Esta región fue la primera del país en contar con este instrumento de planificación y hoy también es la primera en iniciar el proceso de actualización.

26-jun-2018
Cuando las instituciones generan conocimiento e innovación no sólo promueven transformaciones en los ámbitos específicos que impulsan, sino que necesariamente también dotan de valor público al trabajo académico y visibilizan los importantes esfuerzos que se producen al interior de los planteles universitarios en materia de investigación y desarrollo.

26-jun-2018
La acuaponia - integración de la acuicultura con la hidroponía - se consolida como una importante actividad para el agronegocio. Como el sistema se basa en el reciclaje del agua, minimiza la generación de efluentes ricos en nutrientes y evita así la eutrofización de los cuerpos de agua.

25-jun-2018
Frente al explosivo mercado de las imitaciones de vinos y como una forma de asegurar la trazabilidad de uno de los productos de mayor exportación de la región, el Centro de Investigación en Tecnologías de la Información desarrolló innovador sistema de autenticación electrónica.
21-jun-2018
Una nueva clase de materiales, las perovskitas dobles de haluro, pueden tener las propiedades correctas para dividir el agua y producir combustible a partir del hidrógeno y el oxígeno.

19-jun-2018
El objetivo es crear una base de datos de carbono orgánico del suelo, (COS), que aún no existe en Chile y que es de suma importancia para el adecuado manejo sustentable de los suelos. (UdeC).

19-jun-2018
Disminuir o eliminar el uso de herbicidas en huertos frutales, a través del pastoreo directo de los animales, que de forma condicionada consumen sólo las malezas, es uno de los objetivos del proyecto denominado" Ovinos entrenados para controlar malezas en frutales", que ejecuta el Instituto de Investigaciones Agropecuarias, a través de su Centro Regional de Investigación (INIA) Rayentué, con el financiamiento del Fondo de Innovación para la Competitividad, FIC, y el Gobierno Regional de O'Higgins.

19-jun-2018
Chile: Proyecto de investigación de la Universidad de Concepción (UdeC) apoyado por Fundación Copec-UC, Corfo y Brain Chile, convertiría reutilizar los desechos en fuente de alimentos para vacas y pollos, biodiesel, fertilizante e incluso materia prima para cosméticos.

18-jun-2018
En Luján de Cuyo, el INTA abre las puertas de la estación experimental para recorrer las principales actividades que realiza. En nueve senderos, se puede conocer parte de la historia del vino en la región. Esta propuesta se suma a las rutas de atractivo enológico que tiene la provincia.

18-jun-2018
En España, los millennials son los principales consumidores de productos ecológicos u orgánicos y según indican los expertos, las perspectivas de crecimiento del sector vendrán de su mano, por lo que entender sus necesidades futuras de consumo será clave.

15-jun-2018
De acuerdo al Índice Mundial de Innovación, Chile es el líder a nivel regional en esta materia. Pese a esto, en el aporte estatal para la investigación y desarrollo aún se está en deuda.

14-jun-2018
En este intensivo proceso de cambio y transformación tecnológica surgen las Knowledge Intensive Servicies (KIS).

14-jun-2018
En la Región de La Araucanía el rubro hortícola genera una dinámica económica relevante y aún no dimensionada en su totalidad. Según INE (2014), la superficie de hortalizas a escala comercial alcanza a 1.570 hectáreas, con una tendencia al crecimiento interanual (2013/2014) de 29.8%. Esta cifra de superficie aumenta si se lleva a hortalizas bajo sistema huerta casera- consumo–venta de excedentes, donde la superficie sube a 4 mil 526 hectáreas aproximadamente. La producción está marcada por la estacionalidad y se ubica principalmente en las comunas de Renaico, Angol, Nueva Imperial, Padre Las Casas, Temuco y Freire que, en conjunto, representan alrededor del 48% de la superficie regional.

13-jun-2018
Este jueves se realizará en Liceo Agrícola de Yerbas Buenas una Feria para resaltar el Día del Emprendimiento, tal como lo señaló el director Cristian Rivas.

13-jun-2018
Los expositores se dividieron en torno a las salvaguardias solicitadas por los lecheros, debido al impacto a la imagen país. Pidieron avanzar en asociatividad y calidad de los productos.

13-jun-2018
Expertos de la mayor plataforma del conocimiento 22@ dictaron seminario “Camino hacia la innovación empresarial”.

13-jun-2018
El ambicioso proyecto se ejecutará en la Estancia Tehuel Aike Sur y estará asociado a una Central de Prueba de Progenie en Chile

12-jun-2018
La compañía produce, vende y distribuye berries en todo el mundo, todos los días del año.

12-jun-2018
Fortalecer la construcción de un ecosistema efectivo del emprendimiento -entendido como una cultura- y resolver fallas reales del mercado -especialmente, escollos que requieren intervención pública para que el emprendimiento funcione- son los dos aspectos clave con los que centra su eje el nuevo vicepresidente ejecutivo de Corfo, Sebastián Sichel.

11-jun-2018
Comprobaron que una hormona vegetal incorporada en la dieta protege el desarrollo de las larvas de abejas expuestas al frío y otras condiciones de estrés. Los investigadores solicitaron una patente.

08-jun-2018
Bhungroo es un dispositivo que permite acumular el exceso de agua de lluvia bajo tierra para luego ser utilizada durante las estaciones secas.

08-jun-2018
Iniciativa impulsada por el Instituto de Investigaciones Agropecuarias, INIA Quilamapu de Chillán, capacitó a frambueseros de Pinto, Coihueco y Ñiquén pertenecientes al Nodo que está próximo a su término tras dos años de operación en su segunda etapa.

07-jun-2018
Bee Saving Paper es un papel que “funciona como una bebida energética para las abejas”.

06-jun-2018
Red Agroclimática Nacional AGROMET, semana del 04 al 10 de junio de 2018.

05-jun-2018
La nueva herramienta, en cuya creación participa el CSIC, ofrece proyecciones de cambio climático por regiones y actualizadas útiles en ámbitos como la agricultura y la salud. El ‘Visor de escenarios de cambio climático’ de la plataforma AdapteCCa permite a los expertos compartir conocimientos sobre impacto y adaptación al cambio climático en España.

05-jun-2018
La propuesta ya desarrolla su proyecto piloto en Albacete. La depuración de aguas residuales de pequeñas poblaciones, así como de industrias tales como la ganadera, agrícola, vinícola, minera o textil, plantea un reto el cual ya se empieza a intentar solucionar por medio de humedales artificiales, este sistema hace que la solución sea sostenible tanto del punto de vista económico como en la sostenibilidad ambiental.

04-jun-2018
Bautizado como Liquid NanoClay (LNC), esta arcilla líquida permite que incluso el suelo árido del desierto se convierta en un lugar adecuado para la siembra.

04-jun-2018
Mediante el uso de mini satélites, especialistas del INTA Bariloche –Río Negro– evalúan extensas superficies de estepas y mallines del sur argentino para optimizar el manejo ganadero y de pastizales. Una herramienta para orientar la toma de decisiones.

25-may-2018
Las especialistas del Instituto de Investigaciones Agropecuarias (INIA), vinculadas al Centro Tecnológico de Control Biológico de INIA Quilamapu (Chillán), lideran investigación en hongos microscópicos que desde el interior de las plantas estimulan el crecimiento de éstas y combaten plagas y enfermedades que las afectan.

17-may-2018
Se trata de talleres realizados en conjunto con el Centro de Información de Recursos Naturales, CIREN, y CONICYT para desarrollar conocimientos en el área agropecuaria y el manejo sustentable de recursos naturales.

10-may-2018
El Instituto Interamericano de Cooperación para la Agricultura (IICA) lanzará el 28 de mayo, en su plataforma de cursos virtuales, la versión en inglés del “Programa de capacitación Bayer para la facilitación del localg.a.p”, que fortalecerá los conocimientos en materia de buenas prácticas agrícolas (BPA) y en el cumplimiento de la norma mundial que regula este tema, denominada GLOBALG.A.P.

27-jul-2018
Como un ejemplo de cómo la innovación otorga valor agregado a la agricultura y la agroindustria, calificó el Ministro de Agricultura, Antonio Walker, a la empresa Solutec; quienes están desarrollando un proyecto -con apoyo de la Fundación para la Innovación Agraria (FIA)- que utiliza subproductos del poroto granado para obtener ingredientes funcionales para la industria alimentaria.

25-jul-2018
Treehog es un dispositivo de riego para productores de fruta y corresponde a la creación del agricultor sudafricano Louis Loubser, quien ideó un modelo para ayudar a reducir el requerimiento de agua en tiempos de sequía. Sus dispositivos han sido probados en grandes ensayos, con buenos resultados.

23-jul-2018
Investigadores expusieron sobre el origen e importancia de la ocurrencia de heladas en huertos frutales, el origen de las heladas (inversión térmica y masas polares), así como a los manejos agronómicos que se permiten minimizar el daño a los cultivos. (Universidad de Chile).

23-jul-2018
Agregar probióticos a los alimentos de las abejas ayuda a que sean más resistentes a la nosemosis, una infección por hongos asociada con el trastorno del colapso de colonias que se ha observado en Europa y América del Norte en los últimos 20 años. Los probióticos pueden disminuir la tasa de mortalidad de esta infección en las abejas hasta en un 40 por ciento, informan los investigadores de la Universidad Laval.

20-jul-2018
La innovación en el diseño nos está mostrando que necesitamos repensar los recursos disponibles para nosotros. Para muchos diseñadores, el futuro de la fibra no consiste en sacar más recursos de la tierra, sino hacer que crezcan.

19-jul-2018
La inteligencia artificial, el Big Data y el Machine Learning son tecnologías que ganan terreno y generan un cambio de paradigma que divide opiniones. El debate está abierto y los expertos se reunirán en un ciclo de charlas organizado por el INTA y el INTAL-BID.

18-jul-2018
El desafío de aumentar la productividad en el agro chileno, pasa definitivamente por la incorporación de nuevas tecnologías a sus procesos productivos, las cuales permitan mejorar el rendimiento de los cultivos y, a la vez, reducir los costos de insumos y mano de obra.

17-jul-2018
Los tomates tipo cereza o uva son reconocidos por los consumidores debido a la dulzura de su fruta pequeña, alargada, pero una encuesta realizada por la Embrapa Hortalizas desarrollaron un tomate híbrido, y muy dulce, tiene una diferencia beneficiosa para los consumidores indetectables para el gusto: el contenido de licopeno.

16-jul-2018
Actividad organizada por INIA Quilamapu, se desarrollará en Chillán el miércoles 18 de julio y estará principalmente destinada a productores de berries de la zona centro sur.

16-jul-2018
La protección de los cultivos de chile en suelo infestado con bacterias complejas Ralstonia , causando la marchitez bacteriana, Phytophthora capsici y vesícula de nematodos. Este fue el principal objetivo de las investigaciones desarrolladas por la Embrapa Hortalizas (Brasilia-DF) para disponibilizar una variedad de porta-injerto con resistencia múltiple a enfermedades y alta compatibilidad con las variedades hoy en uso comercial.

10-jul-2018
AGLIBS, lanzado recientemente para análisis de suelo en tiempo real, es una de las soluciones que integran una acción del Instituto Mato Grosso del Algodón (IMAmt) para presentar a los productores nuevas tecnologías desarrolladas por la propia institución y socios. La propuesta es divulgar nuevas formas de manejo para dar sustentabilidad a la cotonicultura y al sistema productivo adoptado en Mato Grosso, con el cultivo del algodón tras la cosecha de la soja.

09-jul-2018
España: El riesgo de despoblación es “muy elevado” y “la población rural está muy masculinizada y envejecida”, por lo que “es fundamental atraer a jóvenes y a mujeres”, pero hay que generar unas condiciones de vida y de trabajo atractivas para que la población rural se fije de manera estable.

06-jul-2018
Sin miedo al frío: Se llama heladas a la exposición a temperatura del aire igual o menor a cero centígrados, frente a la que el agua se congela. Heladas intensas por extenso período de tiempo pueden causar daño en tejidos vegetales sensibles.

05-jul-2018
La ministra del Medio Ambiente, Marcela Cubillos, sostuvo que esta legislación será construida desde las regiones a través de un proceso altamente participativo.

04-jul-2018
A menudo nos comportamos como si los recursos fueran ilimitados en un planeta en el que, claramente, no lo son. Cada año, la economía global utiliza más de 90 billones de toneladas de recursos naturales (de los cuales solo el 8% son reutilizados), el equivalente a 1,7 de lo que la Tierra puede producir anualmente. Aunque no se valoran en una hoja de balance, estos recursos valen trillones de dólares para la economía mundial. Este modelo lineal de coger-consumir-tirar no es sostenible.

03-jul-2018
En el marco de su visita a la Facultad de Agronomía e Ingeniería Forestal, el rector conoció detalles del proyecto que dirige el académico Francisco Fuentes, que busca potenciar el cultivo de la quínoa chilena y mejorar sus variedades en nuestro país, entre otros.

03-jul-2018
Investigadores y alumnos de la Universidad Autónoma de Chapingo (UACh) crearon un secador solar que permitirá la conservación de alimentos y así evitar su desperdicio.

30-ago-2018
Antes de haber comenzado el empaque y envío de almendras, el efecto de los aranceles se ha notado en el mercado. Los precios están más bajos que en años anteriores.

30-ago-2018
Ha sido diseñado para agilizar el quehacer institucional en torno a la innovación científico-tecnológica, impulsando tanto la conexión de las capacidades internas como la colaboración con otras entidades. Fue aprobado recientemente por el Consejo Académico.

29-ago-2018
Utilizando recursos informáticos de alto rendimiento, un equipo de investigadores del Laboratoire de Chimie et Physique Quantiques de Toulouse se propuso comprender las interacciones entre los plaguicidas y un componente del suelo. Los resultados nos ayudan a rastrear los niveles de pesticidas en los cursos de agua.

28-ago-2018
Alrededor de 15 familias de las comunidades mapuche Inchin Mapu, Fermin Huaiquimilla, Rayen Quintral, Nehuen Pu Peñi y Lof Pangui, de la comuna de Mariquina, Región de Los Ríos, luchan día a día por preservar sus costumbres y cultura, y lo hacen a través de la recolección de avellanas chilenas, materia prima de su tierra. (Indap).

28-ago-2018
Un arbusto precordillerano conocido como ñipa ha sido la planta seleccionada por dos escolares de la IV Región para desarrollar un jabón antihongos que ocupa el aceite usado en su elaboración como forma de reciclaje. Basándose en las historias de remedios tradicionales, realizaron varios experimentos científicos para comprobar su viabilidad.

28-ago-2018
Las cubiertas plásticas se han desarrollado con fuerza en Chile los últimos 8 años. Su masificación se debe principalmente a la necesidad de proteger las frutas frente a las inclemencias climáticas y asegurar el flujo productivo en el largo plazo. Adicionalmente el aumento de las exigencias de calidad y sanidad del producto, como también la necesidad de producir fruta con menor presión de pesticidas, ha incentivado su uso. Hoy el uso de cubiertas de polietilenos es una tecnología de uso masivo en Italia y España y está creciendo con fuerza en los diferentes países productores de uva de mesa, entre ellos, Chile.

24-ago-2018
La investigación será liderada por académicos de la Facultad de Ciencias Veterinarias y Pecuarias, quienes trabajarán con investigadores de países del bloque, con el objetivo de caracterizar la faena de animales y los canales de comercialización de la carne bovina, apuntando a mejorar la exportación de la producción nacional.

23-ago-2018
Se trata de un Bos Taurus doradillo y mocho que se destaca por su rusticidad, fertilidad, tamaño y mansedumbre. El logro del INTA Leales, Tucumán, constituye una alternativa genética valiosa para los ambientes serranos del NOA.

23-ago-2018
La producción mundial de verduras y legumbres, que son una parte importante de las dietas saludables, podría reducirse significativamente a través de los cambios futuros previstos en el medio ambiente, según una nueva investigación.

23-ago-2018
Ya el Catastro Frutícola de 2015, el último que se ha realizado en Coquimbo, mostraba la caída en superficie de la más importante especie frutícola de la región, la uva de mesa. Esto debido -en parte-, a la larga sequía que se ensañó particularmente con la región, pero además, a los problemas productivos y comerciales de algunas de las más importantes variedades de uva de mesa cultivada en los valles de la región. Sobre esto y las posibles alternativas productivas para pequeños y no tan pequeños agricultores conversamos con José Corral, productor de uva de mesa y vicepresidente de la Sociedad Agrícola del Norte.

22-ago-2018
Científicos se unen para producir filtros de carbón activo, un material con alto contenido en carbono y muy poroso que ayuda a limpiar el agua de ciertos compuestos orgánicos; en particular, la cafeína, un contaminante emergente.

22-ago-2018
El Ministerio de Economía realizó esta semana un seminario en el que analizó en profundidad los datos de la última Encuesta de innovación en empresas, el cual reveló los ámbitos en los que se deben priorizar los esfuerzos de los distintos actores, públicos y privados. La discusión y análisis continuará el próximo martes 21 de agosto.

22-ago-2018
El manejo orgánico de huertos de nogales aborda prácticas tecnológicas que incluyen el manejo de la calidad, fertilidad del suelo, aplicación de abonos orgánicos, biopreparados, uso de cubiertas vegetales y manejo de plagas a través de control biológico.

21-ago-2018
Problemas económicos y violencia, preocupaciones de las y los jóvenes; limitan sus aspiraciones y su avance educativo, revela una encuesta piloto; en reunión, los co-convocantes del Grupo comentaron la encuesta y las posibilidades de incidir sobre políticas esbozadas por el próximo gobierno a favor de la juventud.

20-ago-2018
La recolección de hongos silvestres ha sido una actividad llevada a cabo en el sur de Chile durante cientos de años, lo que la ha transformado en uno de los principales ingresos para un sin número de familias. Comunidades enteras han surgido y forjado su identidad unidas por esta tradicional labor en común. Empedrado es una de ellas.

20-ago-2018
El desarrollo permite realizar la tarea en la mitad del tiempo que las máquinas tradicionales. Además, puede monitorear los lotes para detectar insectos o malezas y aplicar agroquímicos o fertilizantes sólo en los sectores afectados

20-ago-2018
“Esta iniciativa de Rimisp ha enfocado su agenda de trabajo con la juventud rural ecuatoriana y ha identificado, junto con los propios jóvenes dos temas prioritarios e interconectados: la educación técnica y los emprendimientos de jóvenes rurales, como aspectos en los que se demanda mayor atención”, señala, Ney Barrionuevo.

20-ago-2018
Último catastro realizado por el Centro de Información de Recursos Naturales (Ciren) y la Oficina de Estudios y Políticas Agrarias (Odepa), reveló que la Región Metropolitana tiene el 40% de la superficie nacional de plantaciones de nogal. Se trata de la segunda especie frutícola más plantada en Chile tras la uva de mesa.

18-ago-2018
Ambas instituciones se comprometen a desarrollar actividades que beneficien a los habitantes de localidades urbanas y periubanas con la creación de áreas verdes.

15-ago-2018
La quínoa, quinua o kingua (Chenopodium quinoa Willd), es reconocida como un cultivo ancestral, identificada entre las “especies olvidadas y subutilizadas”. Su cultivo data de la época prehispánica donde era un alimento importante para la población de la época, pero con la llegada de los españoles es reemplazada por los cereales.

15-ago-2018
Para controlar las variables que afectan la fisiología y, en consecuencia, la productividad de los cultivos en invernadero, un grupo de expertos, entre ellos de la UNAM, desarrolla un sistema en el que se implementan algoritmos basados en inteligencia artificial.

13-ago-2018
Tras más de dos años de desarrollar diversos análisis e investigaciones, se ha logrado identificar en la sierra del Perú nuevas variedades de papa con resistencia genética a efectos del cambio climático, mejorando la competitividad del cultivo con el incremento de la producción.

13-ago-2018
Es tal la predominancia de la variedad Chandler en la gigantesca industria nogalera californiana y así mismo en la explosiva industria chilena, que no se puede hacer un uso eficiente de la maquinaria de cosecha o de la capacidad de secado. En este escenario, o se dimensiona esta infraestructura en función del cosechón de Chandler o se sacrifica calidad del producto. El doctor Chuck Leslie, líder del programa de mejoramiento genético de nogal de la Universidad de California Davis, describe en este artículo el programa que encabeza y las variedades con potencial que también en Chile podrían complementar a Chandler.

11-ago-2018
Determina las condiciones que tendrá la fruta meses antes de ser cosechada, beneficiará a gran cantidad de productores de la zona central del país.

11-ago-2018
En el Aula Magna y laboratorios de la Escuela de Ingeniería Civil Industrial.

10-ago-2018
Innovaciones de México, Chile y Costa Rica ganaron el Premio INNOVAGRO 2018, anunció la Red de Gestión de la Innovación del Sector Agroalimentario (Red INNOVAGRO).

09-ago-2018
En la región de Coquimbo, la Facultad de Ciencias Agronómicas de la Universidad de Chile dio comienzo al proyecto financiado por Fundación para la Innovación Agraria que busca alternativas sustentables de producción caprina en un escenario de cambio climático.

07-ago-2018
Formará parte de la Comunidad de Práctica (CDP) sobre involucramiento del sector privado en los procesos de política climática en Latinoamérica.

06-ago-2018
A los productores de nuez en el municipio de Nazas, más que el calor les preocupa la posibilidad de una granizada.

06-ago-2018
El secretario general de la Unión de Pequeños Agricultores y Ganaderos de Extremadura (UPA-UCE), Ignacio Huertas, ha estimado hoy que habrá una pérdida de producción del 15 por ciento respecto a la previsiones iniciales que había para esta campaña, fundamentalmente por el calor.

27-jul-2018
Store-bought strawberries: they’re not cheap, especially the organic ones, and they’re often not very good. Both those attributes are related to the fact that strawberries are among the most perishable of produce. It’s a fruit that should be picked when perfectly ripe—meaning the fruit is soft and aromatic—but a perfectly ripe strawberry becomes a rotten strawberry very quickly when placed in a plastic clamshell and shipped around the country. Hence the half-ripe berries, stiff and bland, that you find at the supermarket.

02-jul-2018
Agrícola Natividad es el primer vivero chileno en traer portainjertos clonales de nogales a Chile. Ofrece tres patrones altamente vigorosos como son Vlach, VX211 y RX1, ideales para plantaciones nuevas y replante, permitiendo a la nogalicultura nacional expandirse hacia nuevas zonas, homogenizar los huertos y ganar en precocidad. Cada uno de estos patrones tiene características especiales, como resistencia a nemátodos, sales y phytophtora. Desde que las plantas llegan de Estados Unidos se pone en marcha un proceso técnico de aclimatación, desarrollo y producción que culmina en la entrega de excelentes plantas un año y medio después. Por esta razón se recomienda a los interesados pedir sus plantas con anticipación.

25-sep-2018
El sistema de riego es con tecnología de punta, el cual permite programar turnos de riego a través de equipos móviles.

24-sep-2018
Varios jefes de Estado y de gobierno dieron inicio el lunes a la “Semana del Clima”, celebrada cada año en paralelo a la Asamblea General de la ONU, con el fin de recordar a los líderes mundiales la urgencia de actuar para reducir el calentamiento global.

21-sep-2018
De todas las tecnologías que han revolucionado la industria agrícola, pocas han llegado a los productores más pequeños. Sin embargo, algunos emprendedores están intentando conectarlos con la telefonía móvil, internet y la inteligencia de datos, ante la brecha digital entre los países más y menos desarrollados.

20-sep-2018
La proliferación del empleo de agrotextiles para protección de las plantaciones hortícolas y para sombreado es adecuado para reducir los daños consecuencia de los cambios de clima.

20-sep-2018
La Horticultura interurbana sería mejor disponiendo de agua reciclada de calidad. Los contaminantes agrícolas, una amenaza para el agua del planeta. Más gente, más alimentos, ¿peor agua?.

14-sep-2018
Todavía no tiene nombre y se le conoce por la referencia R36, pero ya está presentada para la obtención de registro de variedades y en un futuro podría revolucionar el mercado de la granada. Se trata de una variedad de piel negra durante todo su proceso de crecimiento y que al madurar, alcanza una coloración más púrpura. En su interior, sus arilos son completamente rojos y destacan su jugosidad, pequeña semilla y sabor muy dulce.

14-sep-2018
La cosecha del arándano está a punto de comenzar en el hemisferio sur. En algunos países, los recolectores ya están trabajando, pero los volúmenes aún son limitados. Los importadores europeos están deseando que llegue la nueva temporada de ultramar. Como el verano ha sido cálido, la campaña europea ha acabado temprano y existe la amenaza de que se produzca un vacío en la oferta. ¿Cuáles son las perspectivas de ultramar? Y ¿cuál es la situación actual en el mercado mundial?

13-sep-2018
En este artículo hacemos un análisis de las tendencias identificadas en innovación y desarrollo de nuevos ingredientes en el IFT18, la feria de tecnología de la alimentación que se celebró del 15 al 18 de julio en Chicago (EEUU), un referente del sector.

12-sep-2018
Un trabajo liderado por el CSIC con uvas de Tempranillo tinto profundiza en el desacoplamiento entre los azúcares y las antocianinas. Debido al cambio climático, la uva llega a la madurez de azúcar cada vez más temprano.

12-sep-2018
Tendencias de producción y consumo de tomates. El dominio del plástico en el envasado está terminándose, ¿cuál es la alternativa?. El Foro del Tomate en Dusseldorf.

10-sep-2018
Milkeeper S busca mejorar los resultados de los ganaderos evitando la muerte de terneros a través de un microorganismo que destruye las bacterias Escherichia Coli y Salmonella spp.

05-sep-2018
Según datos del Banco Mundial, la Tierra ha perdido casi la mitad de su tierra cultivable por persona en los últimos 50 años, mientras que la población no para de crecer y en 2050 alcanzará los 9.800 millones de personas. Para abastecer a todos los habitantes sin agotar los recursos, es necesario transformar la agricultura tradicional para aumentar la producción de manera sostenible, reduciendo el impacto sobre el medioambiente, generando más y mejores empleos para los jóvenes y aumentando la seguridad alimentaria a través de alimentos más seguros y nutritivos para todo el mundo.

04-sep-2018
Protagonista del stand UNITEC, la tecnología Blueberry Vision 2 para la clasificación de la calidad de los arándanos, que permite visualizar el 100% del fruto, tanto interna como externamente, con una fiabilidad sin precedentes.

03-sep-2018
El proyecto de procesamiento y elaboración de productos derivados de la avellana chilena rescata una tradición indígena ancestral y cuenta con el apoyo de Enel Generación Chile.

28-ago-2018
INVERNADEROS. Un estudio de Cuesta Roble -Oak Hill Consulting- especialistas internacionales en producción de hortalizas de invernadero, resume las operaciones de invernaderos anunciadas por los principales fabricantes a clientes distribuidos en 35 países.

30-oct-2018
La provincia de Buenos Aires produce el 75 % de la miel del país. De la mano del INTA, los apicultores agregan valor a sus productos e incrementan sus ingresos. Recaudos para un manejo adecuado en zonas urbanas.

29-oct-2018
El modelo fue el único representante chileno en ganar este destacado premio internacional, en su versión 2018.

27-oct-2018
ESPAÑA: Miles de toneladas de miel de la última campaña se encuentran paralizadas en almacenes de toda España. La causa: las ofertas por las mieles, tanto milflores como monoflorales, son las más bajas de los últimos años, lo que apenas cubre los costes de producción. Todas las organizaciones representativas del sector se han reunido en Madrid para denunciar la “crítica” situación que atraviesan, a la vez que ponen el acento en que se ha sufrido una pérdida de la producción de aproximadamente el 50% respecto a la cosecha de miel de un año normal.

25-oct-2018
ESPAÑA: El sector hortofrutícola apuesta por la transformación digital como herramienta para mejorar los rendimientos y la productividad de las explotaciones y facilitar los procesos de internacionalización.

25-oct-2018
La décima edición de la feria Fruit Attraction ha abierto sus puertas y la innovación se cuela en cada rincón de la muestra. Llegan al producto final, a los envases o al cultivo en el campo.

24-oct-2018
A partir de hoy cientos de extensionistas podrán consultar su teléfono móvil o computador portátil para saber lo que está afectando el rendimiento de diversos cultivos de hortalizas.

24-oct-2018
Las paredes celulares genéticamente modificadas viabilizan la producción de alcohol de segunda generación. Un proyecto científico coordinado por un empleado de una universidad puede causar extrañeza. En particular, en un área como la biológica e involucrando la modificación genética. Este es el caso de Pedro Araújo, técnico del laboratorio del Departamento de Genética, Evolución, Microbiología e Inmunología del Instituto de Biología (IB) de la Unicamp, coordinado por el profesor Marcelo Menossi.

19-oct-2018
ARGENTINA: La empresa Satellogic es una de las pocas en el mundo que construye satélites económicos para monitorizar lo que pasa en cada punto de la tierra en tiempo real

17-oct-2018
La aplicación de la tecnología “blockchain” es vista como una de las grandes promesas de la agricultura para mejorar la trazabilidad de los alimentos, repartir ayuda o mejorar la transparencia, aunque está por ver que tenga beneficios similares para los pequeños productores.

16-oct-2018
Fue elegida por Forbes como una de las 25 AgTechs más innovadoras del mundo por ayudar a los productores de Brasil y de otros cinco países a hacer un uso más inteligente y eficiente de los insumos en sus campos.

12-oct-2018
España: La Diputación de Lleida ha presentado el resultado de un estudio de experimentación realizado durante tres años sobre el regadío en el cultivo del almendro que permite aumentar la rentabilidad de este cultivo.

11-oct-2018
España: Uno de los grandes logros alcanzados por Cooperativas Agro-alimentarias de Andalucía en los últimos años ha sido el concienciar a sus entidades asociadas de la necesidad de promover la igualdad de oportunidades entre hombres y mujeres en todos los estratos de la cooperativa, desde la participación de socios y socias (esto es, agricultores y agricultoras, ganaderos y ganaderas) hasta la incorporación de mujeres en los consejos rectores, pasando por la conformación de plantillas equilibradas y la implementación de planes de igualdad para garantizar la conciliación de la vida personal, laboral y familiar.

10-oct-2018
La agricultura no consiste en limitarse en colocar piedras o ladrillos para construir una pared, su objetivo es construir una catedral: un gran proyecto a largo plazo que requiere el trabajo conjunto de distintos expertos. Esta fue una de las interesantes ideas que Louise Fresco, presidenta de la junta ejecutiva de la Wageningen University & Research (WUR), lanzó en la charla inaugural del congreso de Periodistas Agrarios el pasado julio. Congreso que se celebró precisamente en el campus de dicha universidad, una institución puntera en Holanda con una fuerte vocación internacional.

10-oct-2018
Con el objetivo de presentar nuevos ingredientes para la industria de alimentos funcionales, en base a huevos de gallinas y leche de cabra, bajo modelos de producción sustentable, la empresa Ecoterra y la Fundación para la Innovación Agraria (FIA), lanzaron el “Polo Estratégico de materias primas dedicadas de origen animal para ingredientes Funcionales y Aditivos Especializados para el mercado internacional bajo el modelo de Comercio Justo en la Zona Central”.

08-oct-2018
En un pabellón interactivo, la Universidad mostrará sus últimos adelantos, producto de la investigación y la labor académica que realiza.

08-oct-2018
INIA Carillanca, Chile se adjudica proyecto para el desarrollo de un prototipo biocontrolador en arándanos.

05-oct-2018
Técnicos del INTA elaboraron una colación nutritiva y apta para celíacos a partir del aprovechamiento de las zanahorias que, aún en óptimo estado de madurez, no se comercializan por su forma o tamaño. El volumen de descarte puede alcanzar las 100 toneladas diarias.

05-oct-2018
Un trabajo de investigación llevado a cabo por investigadores del grupo imaPing del Instituto de Agricultura Sostenible (IAS-CSIC-Córdoba), centro adscrito al ceiA3, en colaboración con el Instituto de Ciencias Agrarias de Madrid (ICA-CSIC-Madrid) y la Universidad de Lleida, ha resultado ganador en la 3ª edición del Premio al Artículo Agrario, convocado en el marco de la 64ª edición de la Feria Agraria de Sant Miquel (Lleida) y la 33ª edición del Salón Eurofruit, que se ha celebrado del 27 al 30 de septiembre

03-oct-2018
El programa de mejoramiento genético de patata de Embrapa involucra varias vertientes, entre ellas investigaciones dirigidas al desarrollo de materiales con resistencia a determinadas enfermedades consideradas importantes en la cultura. Este es el caso, por ejemplo, de la evaluación relacionada a la reacción de clones avanzados de patata a la pinta negra, en la región del Alto Paranaíba, en Minas Gerais, donde se concentra buena parte de la producción en el estado.

03-oct-2018
De bajo costo, extracto obtenido puede ser utilizado como suplemento alimenticio.

02-oct-2018
El trabajo, publicado en la revista de alto impacto de la National Academy of Sciences, analizó labor de más de 150 investigadores incluidos tres del Instituto de Ciencias Biológicas de la Universidad de Talca - Chile.

02-oct-2018
El trabajo, publicado en revista de alto impacto de la National Academy of Sciences, analizó labor de más de 150 investigadores incluidos tres del Instituto de Ciencias Biológicas de la Universidad de Talca.

30-sep-2018
Muchos apuestan a que las legumbres son los alimentos del futuro, con su alto aporte de proteínas y nutrientes, pocas calorías y baja huella de carbono en su producción. Y son precisamente las legumbres las protagonistas de este nuevo emprendimiento que pronto llegará a los supermercados.

28-sep-2018
Un equipo internacional de científicos, del que participa el INTA, halló un virus desconocido en la perla antártica, una de las dos especies de plantas que habita el continente helado. El microbio pertenece a la familia Barnaviridae.

29-may-2018
Talca, 29 de mayo 2018.- Con la presencia de cerca de 60 docentes y directivos de liceos técnico-profesionales y liceos rurales de la región del Maule, comenzó el Programa de Formación en “Teoría, práctica y didáctica para la innovación en el aula – Maule 2018”, cuyo objetivo es implementar un programa en emprendimiento innovador para liceos técnico profesionales y liceos rurales de la región del Maule, con el propósito de nivelar conocimientos y dejar capacidades instaladas para la formulación y ejecución de proyectos en innovación y emprendimiento.

26-nov-2018
Los consumidores desean productos nuevos y la industria hortícola mundial está dispuesta a dárselos. Mientras se expande el concepto de lo saludable, están apareciendo hortalizas de tamaños y colores diferentes a los tradicionales, con altos contenidos de vitaminas y antioxidantes. Nadie quiere quedarse fuera de un fenómeno que va en aumento en el planeta.

26-nov-2018
Bioamerica líder de mercado a través de sus líneas de Nutrición Vegetal y Semillas de Hortalizas, tiene como propósito desarrollar e incorporar soluciones que impacten positivamente al entorno, incorporando tecnología que producirá energía solar permitiendo reducir su huella de carbono en 50 toneladas de CO2 al año.

26-nov-2018
El sector no debe conformarse ni descansar en las ventajosas condiciones del país

23-nov-2018
A nivel mundial, el sector agroalimentario enfrenta importantes desafíos derivados del crecimiento demográfico, que ejerce una fuerte presión sobre la demanda de alimentos; el cambio climático presiona para generar una economía menos intensiva en emisiones contaminantes, más eficiente en el uso de recursos naturales, y más resistente a los impactos de este fenómeno.

23-nov-2018
Investigadora de la FEA obtiene concentrado a partir de enzima derivada de microorganismo.

23-nov-2018
Instrumental de control y mediciones

22-nov-2018
El estudio pionero de la Embrapa aprovecha los mecanismos de "memoria" desarrollados por plantas cítricas para una mejor convivencia con situaciones de escasez de agua. La técnica consiste en someter las mudas a situaciones de déficit hídrico durante su formación. Al recibir menor cantidad de agua en ese período, la planta desarrolla una "memoria" que la ayudará a enfrentar ese escenario en el campo, cuando adulto. Esto ocurre porque el desafío impuesto provoca las llamadas alteraciones epigenéticas en el vegetal, modificaciones en el genoma que pueden permanecer estables a lo largo de varias divisiones celulares y que no implican cambio en la secuencia original del ADN.

21-nov-2018
En colaboación con Faenacar y ProChile.

21-nov-2018
La Facultad de Agronomía de la UBA (FAUBA), el INTA Anguil y el Grupo CREA Cabañas finalizaron la evaluación de 43 toros con un innovador sistema de consumo residual diseñado por primera vez en el país. Además de permitir una baja considerable en los costos de alimentación de los animales, esta herramienta podría significar un valioso aporte al mejoramiento genético y a la ganadería local, escribe Juan Manuel Repetto.

21-nov-2018
El Departamento de Agricultura de Estados Unidos (USDA) prevé un aumento en la producción de la industria de carnes bovina, porcina y avícola, lo que tendría un efecto negativo sobre la importación de estos productos en el mercado ruso.

19-nov-2018
(Lima, 16 de noviembre del 2018).- Más de 500 pequeños y medianos agricultores de las regiones de Ayacucho, Arequipa y Tacna se beneficiarán con la ejecución de talleres de capacitación sobre aplicación de técnicas para el uso óptimo del agua y manejo fitosanitario de cultivos que organiza el Ministerio de Agricultura y Riego (MINAGRI), a través del Instituto Nacional de Innovación Agraria (INIA).

19-nov-2018
Considerado uno de los principales problemas de la provincia, la disponibilidad de este recurso natural para consumo humano, producción de carne bovina y riego hortícola es un obstáculo. Recomendaciones del INTA para superarlo.

16-nov-2018
La provincia de Paita ubicada en la región Piura, presenta una gran oportunidad para convertirse en la principal zona productora de uvas de mesa de Perú, señaló hoy Maersk Line.

15-nov-2018
Observaciones del especialista en frambuesas Felipe Rosas. A nivel mundial, la producción de este berry está ya en 600 mil toneladas, no muy lejos del arándano. El mercado más apetecible es en fresco, y Perú cuenta con un gran activo como el aeropuerto Jorge Chávez que está a pocas horas de destinos clave. Además, el cultivo puede ser importante para la inclusión de regiones del interior.

15-nov-2018
El nuevo sistema propone mayor eficiencia para seguir la ruta de un producto, sus componentes, materias primas, actores involucrados e información asociada, desde el origen hasta el punto de destino final. Continuarán las capacitaciones.

14-nov-2018
Se presentaron en el C3 productos para proteger cultivos de insectos y hongos, que funcionan en base a principios biológicos.

13-nov-2018
El proyecto vencedor de entre 14 finalistas fue Chevolek, destinado a una higiene de vacunos más pasiva y menos agresiva que la convencional.

13-nov-2018
Con el objetivo de promover la obtención de variedades competitivas en el mercado, el INTA y el INIA Uruguay firmaron un convenio para el intercambio de material genético. Se realizó en el marco del Consorcio Regional de Papa, creado en el ámbito del Procisur.

12-nov-2018
En la Patagonia argentina, el cultivo de plantas sin uso del suelo se realiza en invernaderos y permite asegurar el consumo de verduras de hoja durante todo el año. El INTA y la empresa familiar Hidroponia Andina organizan el segundo curso internacional sobre la temática.

12-nov-2018
Especialistas de los principales centros de investigación del país se reunirán el miércoles 21 de noviembre en INIA Quilamapu para tratar los aspectos que inciden directamente en las prácticas y los cultivos agrícolas.

12-nov-2018
SAN NICOLÁS. Proyectos presentados en el Savialab BioBio fueron favorecidos.

09-nov-2018
“¿Cuánto ha viajado una fresa desde que se la cosecha de la planta hasta que llega a tus labios?” es la pregunta que hace Liz Cookman, en el artículo que publica en The National, de Emiratos Árabes Unidos. Ella cuenta el largo viaje de los productos para llegar a los mercados de los EAU y la solución proporcionada por una empresa francesa a través del cultivo hidropónico.

08-nov-2018
Los frutos secos son alternativas a otros frutales y tienen posibilidades en la actual alimentación y modernas tecnologías alimentarias; en producción ecológica, lucha contra la despoblación rural, cambio climático y mantenimiento del paisaje.

06-nov-2018
ESPAÑA: El Centro de Investigaciones Científicas y Tecnológicas de Extremadura (CICYTEX) trabaja en un proyecto para diversificar la oferta de cultivos de plantas medicinales y aromáticas, con producciones sostenibles de alta calidad, en Extremadura. Los ensayos de campo se realizan con distintas especies: orégano, tomillo salsero, lavanda, hierba luisa, tomillo limón y melisa, al que se irán integrando en campañas sucesivas otras especies de interés para la región. El objetivo es evaluar su comportamiento agronómico, manejo del cultivo y los rendimientos a escala real de explotación. En 2019 está previsto la publicación de un manual de cultivo para alguna de las especies estudiadas.

05-nov-2018
Con una serie de iniciativas que abarcan los ámbitos de la transferencia tecnológica y el emprendimiento, la Universidad de Talca realizará actividades en todos sus Campus para promover un ecosistema innovativo.

05-nov-2018
PERÚ: El Ministerio de Agricultura y Riego (MINAGRI), a través del Instituto Nacional de Innovación Agraria (INIA), realizó el lanzamiento oficial de seis proyectos de investigación y transferencia de tecnología, en cultivos que tienen gran impacto en la agroexportación.

30-oct-2018
Publicación del Sub Departamento de Información, Monitoreo y Prevención IMP – DGIR. Ministerio de Agricultura.

28-dic-2018
Un total de 523 alumnos participaron durante el 2018 del programa de innovación escolar SaviaLab, iniciativa que en su quinto año de funcionamiento ha logrado convertirse en uno de los motores de la innovación temprana en estudiantes de liceos técnicos, y cuyo objetivo es la incorporación de una mirada diferente e innovadora sobre la realidad local.

28-dic-2018
Mediante jornadas de trabajo en terreno, los agrónomos Francisco Vio y Javier Soler explican a quienes les visitan formas de planificación, preparación y cultivo de la tierra, herramientas de trabajo, organización, y prácticas sustentables para un proceso exitoso.

28-dic-2018
PAILLACO. La agrupación "Domo Peuma" nació en 2015. Sus desafíos son trasladar la planta procesadora y obtener la resolución sanitaria.

21-dic-2018
Investigadores del INTA y de la Universidad Nacional de San Martín utilizaron “tijeras génicas” para modificar el genoma de embriones producidos in vitro. En tres de cuatro animales, editaron el gen de la beta-lactoglobulina, principal alérgeno presente en la leche bovina.

20-dic-2018
El libro que recoge las experiencias de 71 investigadores de todo el mundo sobre el control biológico de fitopatógenos, insectos y ácaros en el sector agropecuario, fue editado por la investigadora de la Corporación colombiana de investigación agropecuaria (AGROSAVIA), Ph.D. senior Alba Marina Cotes. Se trata de un libro de 1.200 páginas que ha sido digitalizado y publicado en internet para descargarlo libremente.

20-dic-2018
La ministra del Medio Ambiente, Carolina Schmidt, destacó que el país sea sede de la COP25, cita de dos semanas de duración que reunirá a ministros y jefes de Estado de 197 países. “Representa un desafío enorme, el que asumimos como un hito histórico que nos permitirá seguir avanzando como país en el desarrollo sustentable y en nuestro compromiso con el medio ambiente”, sostuvo la secretaria de Estado.

19-dic-2018
Miembros de un equipo de investigación de la Universidad de Cádiz, España, han desarrollado un método para analizar los posibles aditivos incluidos en el edulcorante natural, uno de los diez alimentos más adulterados del mercado. Los resultados obtenidos demuestran que la aplicación de este modelo de selección podría ser una herramienta útil para un análisis de calidad en laboratorios de rutina (Agencia Sinc).

19-dic-2018
Permiten vigilar temperaturas y humedad, entre otros datos, de campos, reemplazando a los actuales drones.

19-dic-2018
El crecimiento del mercado mundial de productos orgánicos ha continuado en 2018 y Norteamérica ha consolidado su posición de liderazgo. Ecovia Intelligence (anteriormente conocido como Organic Monitor) proyecta que las ventas de alimentos orgánicos regionales superarán los USD 50 mil millones por primera vez este año.

17-dic-2018
Científicos creen haber descubierto en Finlandia la primera vacuna en el mundo para proteger a las abejas y evitar el desplome de la población de estos insectos, lo que podría causar una crisis alimentaria mundial.

14-dic-2018
La Organización de las Naciones Unidas para la Alimentación y la Agricultura (FAO) y el gobierno de Suiza invitan a personas individuales, empresas o instituciones a presentar sus postulaciones antes del 28 de febrero de 2019.

14-dic-2018
El presidente del Instituto Nacional de Carnes (INAC) de Uruguay, Federico Stanham, señaló que las proyecciones de venta para 2018 alcanzarían los USD 1.940 millones, casi un 5% más que en 2017, con China como principal destino.

13-dic-2018
El evento meteorológico del pasado 12 de noviembre ha generado cuantiosos daños, sobre todo en las regiones de O’Higgins y del Maule. Ante este escenario, es relevante conocer qué acciones se pueden ejercer para ayudar a los cultivos afectados, evitando un escalamiento en las pérdidas.

13-dic-2018
Un Sistema de Monitoreo de Cultivos y Clima (SMC) pondrá en marcha el próximo año el Centro Nacional de Tecnología Agropecuaria y Forestal “Enrique Álvarez Córdova” (CENTA) junto con el Programa Mundial de Alimentos (PMA), con el objetivo que el personal técnico de las 40 Agencias de Extensión agilice el procesamiento de la información referente a la situación de los cultivos en el campo.

12-dic-2018
La Vicerretoría de Innovación y Transferencia Tecnológica creó programa de formación de I+E para entregar herramientas a docentes e investigadores que faciliten los procesos de investigación, transferencia tecnológica y emprendimiento.

11-dic-2018
La iniciativa de formar Perú BioRed surgió durante el X° Encuentro de la RedBioLAC (Red de Biodigestores Para Latino América y el Caribe) realizado en Foz de Iguazú en septiembre del 2018. Perú BioRed fue fundada el 11 de octubre de este año como consecuencia de las experiencias y convicciones compartidas sobre la importancia de esta tecnología en el país y en el mundo.

05-dic-2018
Investigadores del INTA, del Conicet y de las universidades de Morón y de Buenos Aires, estudian las propiedades de la planta conocida como campanilla para el tratamiento de enfermedades neurodegenerativas y depresión concomitante.

05-dic-2018
En la escuela rural de Lenca se realizó un día de campo, convocado por el Centro de Estudios CEUS Llanquihue de la Universidad de Santiago. El objetivo era revisar los avances que ha tenido el proyecto “Desarrollo de tecnologías de cultivo sustentables y económicas para el establecimiento de la agricultura rural salina del espárrago de mar (Salicornia sp) en la zona costera de la región de Los Lagos”, así como potenciar los usos de este cultivo.

05-dic-2018
Diversas investigaciones revelan que, desde la época prehispánica, los pigmentos naturales se han usado para la elaboración de colorantes utilizados para pintar murales, vasijas, códices e inclusive para el tatuado y grabado del cuerpo humano y la vestimenta utilizada en los rituales mágico-religiosos.

03-dic-2018
El 27 y 28 de noviembre, en dependencias del Instituto de Investigaciones Agropecuarias (INIA) de Chile, se realizó el taller “Frutos nativos de la región e intercambio con la industria”, con el fin de impulsar el desarrollo de ingredientes de origen natural, como colorantes y antioxidantes, a partir de frutos nativos de los países que forman parte del PROCISUR.

28-nov-2018
El estudio pretende contribuir a la seguridad y la calidad de los frutos y de sus derivados.

27-nov-2018
Curarrehue, 26 de noviembre 2018.- Con la presentación de una barrita sustentable en base a productos nativos como brotes de coligue, changle y nalca, se realizó el cierre del proyecto “Encadenamiento productivo y asociativo saludable y sustentable Mawiza Newén”, con el apoyo de la Fundación para la Innovación Agraria, FIA .

27-nov-2018
Fue desarrollado por investigadores del INTA Balcarce y la Facultad de Ciencias Agrarias junto con la Asociación de Ingenieros Agrónomos local. Brindará recomendaciones para prevenir el desarrollo de fuegos y se actualizará dos veces por semana.